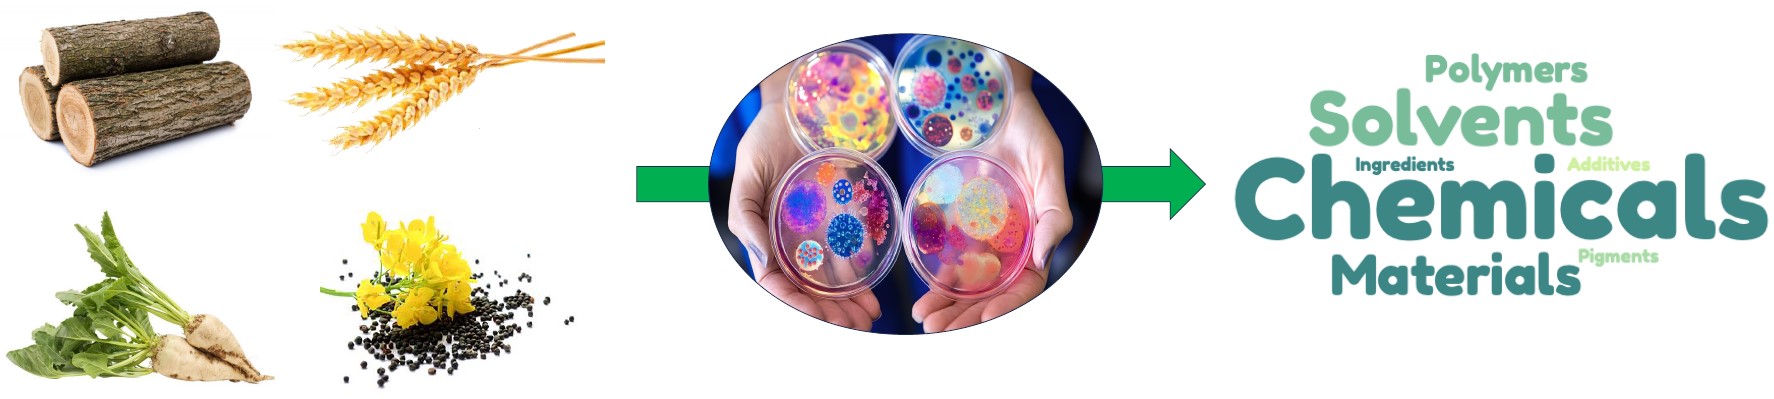

Bio-based epoxy thermosets from 2,5-furan dicarboxylic acid derivates with tunable chain length

Due to safety concerns over bisphenol-A-based epoxy thermosets, many European countries have implemented stricter regulations, increasing the demand for bio-based alternatives. In this view, furan-based monomers, such as 2,5-furandicarboxylic acid (FDCA) derived from carbohydrates, have been widely explored as sustainable building blocks for high-performance epoxy resins. However, most studies focused on short-chain FDCA-derived epoxides, like C3-based glycidyl ester derivatives, with little research on FDCA-derived epoxides of varying chain lengths. Building on these premises, this work focuses on synthesizing a new family of bisepoxide FDCA monomers with chain lengths of four, six, and ten carbons.
These bio-based monomers were synthesized via oxidation of α,ω-diene ester furan monomers and thus thermally cured using two bisamine hardeners, namely 4,4′-methylenebis(cyclohexan-1-amine) and 4,4′-methylenedianiline leading to FDCA-based epoxy thermosets. Structural analysis confirmed the successful curing and crosslinking of these monomers. Data collected highlighted the influence of the monomer length on the properties of the thermoset materials, with longer bisepoxide monomers exhibiting enhanced thermal stability and flexibility.
it was found that the length of the bisepoxide monomer also affected the crosslinking density of the final materials. Interestingly, the bisepoxide FDCA monomer with six-carbons chain cured with 4,4′-methylenedianiline showed the highest crosslinking density, comparable to conventional DGEBA-based thermosets. Finally, a simple methanolysis can efficiently depolymerize the thermoset into its starting monomer, FDCA dimethyl ester, and a polyol offering potential for recycling or the development of new polymers.
Integrated online DPPH-assisted multimodal dereplication workflow for identifying antioxidant compounds in complex mixtures and its application to a supercritical CO2 extract of Makwaen pepper by-product
The identification of bioactive compounds in complex natural extracts remains a major challenge, particularly in the context of the sustainable valorization of by-products. In this study, an integrated dereplication strategy combining online 2,2-diphenyl-1-picrylhydrazyl (DPPH) assisted screening, high-resolution mass spectrometry (HRMS/MS), and 13C nuclear magnetic resonance (NMR) based chemical profiling was developed to identify free-radical scavenging compounds in a supercritical CO₂ extract of Makwaen pepper (Zanthoxylum myriacanthum) by-product.
A comprehensive offline centrifugal partition chromatography (CPC) and high-performance liquid chromatography (HPLC) coupling was employed to fractionate the extract, enhancing sensitivity and facilitating structure elucidation. The CATHEDRAL annotation tool was used to classify compounds based on annotation confidence levels, integrating data from HRMS/MS and NMR workflow. A total of 50 active compounds were identified, including flavonoids, caffeic and quinic acid esters, phloroglucinols, and lignans. This workflow provides a rapid and robust approach for dereplicating antioxidants in natural extracts, supporting the development of sustainable bioactive ingredients for cosmetic applications.
Chemical and enzymatic synthetic routes to the diglycidyl ester of 2,5-furandicarboxylic acid

This work focuses on alternative, green synthetic methods for producing a bio-based bis-epoxy compound – namely bis(oxiran-2-ylmethyl) furan-2,5-dicarboxylate (DGF) – in consideration of its potential use as monomer for epoxy resins. The synthesis of DGF was conducted via transesterification reaction of 2,5-furandicarboxylic acid dimethyl ester (FDME) with glycidol. A variety of homogeneous, heterogeneous, and enzymatic catalysts were investigated, and the syntheses were carried out avoiding any chlorine-based chemicals and employing green media.
The homogeneous route yielded the best results when the reaction was conducted in 2-Me-THF as medium and using triethylamine as a catalyst. DGF was isolated as pure in 82 % yield through a simple liquid-liquid extraction. In the heterogeneous route, triethylamine immobilized on a polymeric polystyrene-divinylbenzene (PS-DVB) support, led to a lower yield due to a moderate substrate conversion. The chemo-enzymatic route employed Candida antarctica lipase B (CAL-B) supported on various Supported Ionic Liquid-Like Phases (SILLPs)
In this case DGF yield was only 10–20 %. Interestingly, the reaction led to similar results even in the absence of the enzyme, suggesting that the ionic liquid-like phase on the resin was not a passive support, but it actively participated in promoting the transesterification reaction. Thus, the efficiency of several SILLPs as catalysts was evaluated. Among them, the butyl imidazolium chloride SILLP demonstrated superior catalytic performance compared to supported alkyl ammonium salts leading to 79 %. Furthermore, its stability was very promising, maintaining consistent catalytic efficiency over 12 consecutive cycles.
Biocatalysis, a great toolbox for the upgrading of biomass
The development and application of biocatalysis have evolved significantly, from the classical use of commercial enzymes to the production, modification and implementation of non-commercially available enzymes, driving advancements in sustainable bioprocesses for bio-based chemical and material production. We have focused on combining chemistry, biocatalysis and process intensification, to create efficient (chemo)enzymatic routes capable of transforming renewable raw materials into valuable industrial products. The portfolio of biocatalysts has been expanded through the integration of biocatalysis and green chemistry principles, facilitating innovative, eco-friendly alternatives to traditional petrochemical processes and supporting the transition towards a circular bioeconomy.
Development of a Tailored Culture Medium for Improved De Novo Biosynthesis of Ferulic Acid in Fed-Batch Biphasic Fermentation with Saccharomyces cerevisiae

Ferulic acid (FA) is a natural phenolic compound with diverse biological properties, widely used in the food and cosmetic industries. Its production from fermentation is a promising strategy because its extraction from biomass is costly. To enable cost-effective microbial production, medium optimization is mandatory. In this study, we focused on applying a fed-batch biphasic strategy for the production of ferulic acid (FA) from d-glucose. FA production was first assessed in a classically defined medium, 2X Yeast Nitrogen Base (YNB) without amino acids, and complex Yeast Peptone Dextrose (YEPD) medium. Finally, as FA has deleterious antimicrobial properties, continuous extraction from the broth using fed-batch biphasic fermentation was implemented.
Our results showed that YEPD medium resulted in the production of 207 mg·L−1 of FA in a medium composed of 30 g·L−1 d-glucose, 10 g·L−1 yeast extract, 1 g·L−1 (NH4)2SO4, 10 g·L−1 peptone, 4 g·L−1 KH2PO4 and 2 g·L−1 K2HPO4. Fed-batch biphasic fermentation system resulted in almost a two-fold increase in FA production compared to batch one (312.6 mg·L−1 and 176.7 mg·L−1, respectively) showing the importance of fed-batch biphasic fermentation and medium detoxification.

Hemicelluloses have immense potential for applications in diverse fields, especially in polymeric materials. This review critically examines biomass treatment technologies, encompassing chemical, mechanical, and combined approaches to disrupt plant cell walls and enhance hemicellulose accessibility and solubility. The choice of a treatment method depends on factors like purpose, biomass composition, and economic and environmental considerations. Hemicelluloses extracted from wood are composed from up to 11 monomer units, most of them “neutral” monosaccharides (glucose, mannose etc.) but a couple “charged” (uronic acids).
The average compositions of wood hemicelluloses change with the type of wood; the accuracy is not known. The content of “charged” monosaccharides may particularly suffer from underestimation due to strong hydrolysis. The chemical composition of intact wood hemicelluloses has never been determined: it is thus not known if hemicelluloses in wood are a mixture of several “simple” polysaccharides (such as glucomannans) or complex polysaccharides with up to 11 monomer units in the same macromolecule.
Currently determined molecular weights (MW) of hemicelluloses range from 500 to 1,000,000 Da. The precision and accuracy of MWs are not known, primarily due to column inconsistency in analyzing anionic and neutral polymers. A combination of chromatography SEC methods and detectors is required for standardization.
The Impact of Thermal and Electrical Pretreatments and Antibrowning Solution on the Chlorogenic and Dicaffeoylquinic Acid Extraction Yield from Endive Roots

Forced endive roots (FERs) contain beneficial antioxidant compounds such as chlorogenic acid (5-CQA) and dicaffeoylquinic acids (diCQAs). This study compared the extraction yields of 5-CQA and diCQAs using a biomass pressing method with various pretreatments, including pulsed electric field (PEF) and microwave (MW), against the solid–liquid extraction method (water, 90 °C, 30 min). The results indicated that the MW pretreatment achieved the highest yields, extracting 28 ± 2% of 5-CQA and 13 ± 1% of diCQAs, surpassing the solid–liquid method. Furthermore, the oxidative degradation of CQAs was studied, and it appeared that this reaction was enhanced by PEF pretreatment. An antibrowning solution (ABS) was successfully tested to reduce this oxidation and protect CQAs. An extraction process utilizing MW and PEF pretreatments combined with an ABS solution achieved yields of 65 ± 1% for diCQAs and 80 ± 5% for 5-CQA, significantly outperforming the solid–liquid extraction method.
Green synthesis of enantiopure 5-O-feruloyl-2-deoxy-D-ribono-γ-lactone, 5-O-feruloyl-(S)-4-(hydroxymethyl)-γ-butyrolactone and analogues from lignocellulose-derived p-hydroxybenzaldehydes and levoglucosenone

Enantiopure 5-O-feruloyl-2-deoxy-D-ribono-γ-lactone, 5-O-feruloyl-(S)-4-(hydroxymethyl)-γ-butyrolactone and analogues were successfully synthesized from lignin-derived p-hydroxybenzaldehydes and cellulose-derived levoglucosenone using a sustainable convergent route involving a Meldrum's acid opening strategy and Knoevenagel-Doebner condensation as key steps. Selected compounds were then reduced using palladium-catalyzed hydrogenation to produce the corresponding saturated esters.
The antioxidant, UV-filtering activity, as well as photostability, of the synthesized compounds were assessed using DPPH analysis and UV–vis spectroscopy, respectively. Structure-activity relationships were then established and revealed the most promising phenolic esters.
Halogen-Free Synthesis of α,ω-Dienes and Antioxidant Oligomers from Vanillin

This study introduces a synthetic route for multifunctional α,ω-dienes using vanillin and Knoevenagel–Doebner condensation, overcoming limitations of traditional methods by avoiding halogenated reagents and preserving free phenol groups. The structural features of prepared α,ω-dienes were corroborated by 1H NMR, 13C NMR, 2D NMR, and HRMS. Antioxidant lignin-derived oligomers Poly(BV-ButM), Poly(BV-HexM), and Poly(BV-DecM) were subsequently elaborated via acyclic diene metathesis polymerization (ADMET) using the green solvent cellulose-derived isosorbide.
The catalyst screening was performed employing three various metathesis ruthenium-based catalysts: GI, GII, and HGII. The thermal properties as well as the molecular weights of oligomers were explored by DSC, TGA, and GPC analyses. Depending on the catalyst used, Poly(BV-ButM) exhibited Mw (0.6–1.1 kg mol–1), Tg (85–115 °C), and Td5% (225–245 °C); Poly(BV-HexM) exhibited Mw (1.4–1.8 kg mol–1), Tg (61–63 °C), and Td5% (237–306 °C); and Poly(BV-DecM) exhibited Mw (1.5–2.6 kg mol–1), Tg (32–46 °C), and Td5% (239–344 °C).
Moreover, the antioxidant properties were also assessed by a DPPH assay, showing that the developed oligomers possess a higher antioxidant activity compared to the commercially available antioxidants Irganox 1010 and ferulic acid, highlighting their ability to be used as an antioxidant polymer matrix or antioxidant additives for food packaging. In summary, we have developed a novel green synthetic strategy enabling the synthesis of multifunctional α,ω-dienes with free hydroxyl groups from renewable phenolic compounds that lead to oligomers with antioxidant properties.
Purification of sinapic acid from mustard bran enzymatic hydrolysate by adsorption on macroporous resins

This work focuses on the adsorption chromatography process to purify sinapic acid from mustard bran hydrolysate, an agro-industrial by-product generated in large quantities during mustard seed processing. The adsorption and desorption capacities of sinapic acid on four macroporous adsorbent resins were determined in batch mode, for both a real hydrolysate and model solutions.
The results showed that the best adsorption capacity was obtained with XAD16 and FPX66 resins and adsorption isotherm data were well represented by a Langmuir model. The desorption ratios by ethanol were high, with a maximum value of 98 ± 1% at 90% (v/v) ethanol fraction for XAD16 resin. XAD16 resin was selected for the dynamic purification, and optimized results showed an adsorption capacity of 75.6 mg/g for sinapic acid, corresponding to a breakthrough volume of around 50-fold of the resin bed volume (BV) at the feed flow rate of 2 BV/h. Complete desorption was achieved with 8 BV of 90% (v/v) ethanol at the elution flow rate of 2 BV/h, resulting in a recovery yield of around 97%. The purification process achieved an 8.6-fold concentration of sinapic acid, with a 37-fold increase in purity (from 0.50% to 18.42%) and a 7.4-fold enhancement in potential antioxidant activity, reaching 341 ± 24 mg of Trolox equivalents/100 mL.
This process has been proven to be highly efficient and could contribute to the design of industrial-scale purification of sinapic acid from mustard bran hydrolysate.
Molecular Heaters: A green route to boosting crop yields?

ood production and food security are fast becoming some of the most pressing issues of the 21st century. We are developing environmentally responsible molecular heaters to help boost crop growth and expand geographic areas capable of supporting growth. Sinapic diacid (SDA) is such a molecule, that can act as a light-to-heat agent, converting solar energy into heat delivered to the plant. We have characterised the photophysical properties of SDA extensively, using a combination of steady-state and ultrafast laser spectroscopy techniques complemented with high-level computational studies, and demonstrated both its resilience to prolonged solar irradiation and light-to-heat capabilities. The results we present here illustrate the untapped potential of molecular heaters such as SDA to boost plant yields in existing growing regions and to expand growth into regions hitherto considered too cold for crop growth.
Sustainable Synthesis of Terpolyesters Based on a Levoglucosenone-Derived Cyclic Acetal Diol

Biobased polyesters are gaining increasing interest as sustainable replacements for traditional fossil-based polymers. The compound (1R,2S,5R)-6,8-dioxabicyclo[3.2.1]octane-2,4-diol (HO-LGOL) is a cellulose-derived monomer that can be used to synthesize polyesters with properties similar to those obtained with classical reagents. In this work, several HO-LGOL-based copolymers were sustainably synthesized in the green solvent dioxolane Cygnet (0.0) (referred to as “Cygnet 2”) utilizing Candida antarctica Lipase B (CaLB) as a biocatalyst. HO-LGOL was reacted with dimethyl adipate and aliphatic diols of various lengths. Different ratios of reactants were also investigated, and an equimolar amount of HO-LGOL and aliphatic diol was found to yield copolymers with the highest level of HO-LGOL incorporation. Matrix-assisted laser desorption ionization-time-of-flight mass spectrometry (MALDI-TOF) confirmed the structure of end groups and the presence of HO-LGOL in longer polymer chains. The incorporation of HO-LGOL resulted in terpolymers with an HO-LGOL content of up to 49% (relative to the aliphatic diol), which exhibited lower crystallinity and higher thermal stability compared to the corresponding aliphatic homopolymers.
Pigments production from a newly isolated psychrotrophic strain of Epicoccum nigrum grown on non-sterile exhausted sugar beet pulp through solid state fermentation

The potential of a new strain of Epicoccum nigrum to produce isomers of epipyrone A as pigments was investigated using solid state fermentation. A first screening of solid byproducts used as substrates revealed that exhausted sugar beet pulp maximized the production of pigments thanks to its higher pectin content. A subsequent optimization of the culture conditions using a central composite design was then carried out and allowed to determine optimal moisture content of 70% and optimal temperature of 23°C. On the second hand, the possibility of growing the strain on a non-sterilized medium was investigated using a respirometry approach: the growth parameters of the strain of E. nigrum were compared with those of the endogenous microflora of the medium at different temperatures (23, 17.5, 12 and 7°C). At 12 and 7°C the fungus had shorter lag duration values than potential competitors from the substrate. Afterward, cultures were carried out in tray bioreactors (1 kg of dry medium, 30 cm bed height) at the same temperatures on previously sterilized medium and non-sterile medium. Analysis of pigments production and targeted metagenomic studies showed that, as suggested by respirometric data, at 23 and 17.5°C, the pigments production was hindered because of the development of endogenous fungal competitors and temperature rise. On the other hand, at 12 and 7°C, no temperature gradients and no differences could be observed in pigments production and fungal communities’ composition under both modalities of sterility. This study provides insights concerning the use of psychrotrophic microorganisms to remove the sterilization step without contamination issues, hence reducing the overall costs of a biotechnological process and improving the easiness of its implementation.
The challenges faced by multifunctional ingredients: A critical review from sourcing to cosmetic applications

In response to the growing consumer demand for natural ingredients and simplified formulations, the cosmetic industry has seen a surge in the development and application of multifunctional ingredients. These versatile components, capable of serving multiple roles, effectively streamline the ingredient list of final cosmetic products, aligning with the current market trends. This review provides an overview of the advancements made and limits encountered in the field of multifunctional cosmetic ingredients over recent years (from 1998 to present time). The pursuit of sourcing these multipurpose ingredients has become a significant focus, with a clear shift towards natural and bio-based products, while answering the requests of consumers for eco-friendly options. By prioritizing sustainable and ethics, researchers not only adhere to regulatory standards but also pioneers innovations that set new benchmarks for quality and responsibility. The review also delves into formulation strategies for multifunctional ingredients, a critical aspect of their development process. It discusses the various approaches adopted by researchers to effectively incorporate these ingredients into cosmetic products, ensuring their safety and stability. Lastly, the review addresses the regulatory landscape surrounding cosmetic ingredients. It underscores the importance of adhering to the regulations set forth by governing bodies, ensuring the safety and efficacy, and highlights the lack of dispositions for these innovative multifunctional ingredients. In conclusion, this review offers a comprehensive insight into the multifunctional cosmetic ingredients, from their sourcing and formulation to their application and regulation, providing a valuable resource for researchers and industry professionals alike.
Tuning thermo-mechanical properties of elastomeric lactic acid-based copolymers for biomedical applications

Several biomedical polymers are widely utilized by surgeons as implants, bone cements, or sutures. This study focuses on plasticizing biomedical grades of innovative bioresorbable polymers based on lactic acid, using a derivative of ferulic acid as the plasticizer, aiming to attain properties appropriate for use as sutures. The thermo-mechanical properties and biocompatibility of the resulting polymer blends were thoroughly evaluated. A blend consisting of poly[DL-lactide-co-poly(ethylene glycol)] with 30 w% of plasticizer exhibited a significant increase in elongation at break, from 11% to 598%. The tensile strength of the plasticized poly-(L,L-lactide)-co-glycolide reached 19.8 MPa, comparable to a standard polypropylene suture. Microscopic analyses showed the migration of the crystallized plasticizer to the surface of the blend. Not only did cell culture tests confirm the biocompatibility of the blends but also blends did not promote cell or bacterial proliferation on their surfaces, indicating their potential suitability for sutures where the biological inertness of the biomaterials is required. These results demonstrate the feasibility of significantly enhancing the thermo-mechanical properties of commercially available polymers, already used for medical applications, without compromising their biocompatibility, solely through the addition of a non-reactive additive.
Environment-Dependent Ultrafast Photodynamics of Aurone Derivatives for the Photoprotection of Agrochemicals

Derivatised aurones, based on phytochemical flavonoids, were synthesised and studied using steady-state and ultrafast spectroscopy techniques. Aurones’ strong ultraviolet (UV) and visible absorption, in addition to being found in abundance in fruits, vegetables and flowers, makes them ideal photoprotection candidates for agrochemicals. Agrochemicals are well known to exhibit poor photostability, and the addition of photoprotectants to their formulations thus increases their longevity, and thereby environmental sustainability. The results presented here shed light on the complex ultrafast and long term photodynamics of five nature-inspired derivatives in solution and on a wax surface, the latter designed to mimic the cuticle of a plant leaf. This study finds markedly different relaxation mechanisms between these condensed phase environments, highlighting the importance of studying photoprotectants in their real-world environments. These findings inspire the development of safe and effective photoprotectants for agrochemicals.
Thiol-Ene UV-Cured Biodegradable Coatings from α,ω-Diene Furanic Monomers

Biobased monomers are gaining significant attention in today’s global efforts toward sustainable development. C6-furanic platform chemicals, derived from biomass, are considered to be promising building blocks for biorefineries, offering the potential for the development of sustainable polymer materials. This study investigates the synthesis and photocuring of two biobased α,ω-diene furanic monomers─diallyl furandicarboxylate ester (All-FDE) and diallyl furanmethyl carbonate (All-FMC)─for use in UV-cured coatings. These monomers, derived from renewable resources and synthesized using green chemistry principles, were used in thiol-ene photocuring reactions with trimethylolpropane tris(3-mercaptopropionate) as the thiol. Real-time FTIR and photo-DSC analyses showed rapid, near-complete conversion under UV light. All-FDE formulations exhibited higher glass transition temperatures (Tg) compared to All-FMC due to increased cross-linking density. Both materials were fully degradable in alkaline conditions, with All-FDE degrading faster. This research demonstrates the potential of biobased monomers for ecofriendly, degradable coatings via UV curing.
Development of an In Situ G Protein-Coupled Receptor Fragment Molecule Screening Approach with High-Resolution Magic Angle Spinning Nuclear Magnetic Resonance

Small molecules are essential for investigating the pharmacology of membrane proteins and remain the most common approach for therapeutically targeting them. However, most experimental small molecule screening methods require ligands containing radiolabels or fluorescent labels and often involve isolating proteins from their cellular environment. Additionally, most conventional screening methods are suited for identifying compounds with moderate to higher affinities (KD < 1 μM) and are less effective at detecting lower affinity compounds, such as weakly binding molecular fragments. To address these limitations, we demonstrated a proof-of-concept application of high-resolution magic angle spinning nuclear magnetic resonance (HRMAS NMR) spectroscopy with small molecules that bind the human A2A adenosine receptor (A2AAR), a class A G protein-coupled receptor. Our approach leverages a streamlined workflow to prepare NMR samples with only milligrams of unpurified cell membranes containing ∼1 μM of A2AAR. Utilizing saturation transfer difference NMR, we identified bound small molecules from spectra recorded within minutes and further derived information on ligand binding poses without the need for detailed structure determination. After establishing optimal criteria for which the HRMAS approach is most sensitive, we leveraged our HRMAS approach to identify and characterize molecular fragments not previously known to be ligands of A2AAR. In molecular docking and simulations, we observed novel binding poses for these fragments, which revealed the potential to grow them into more complex ligands and confirmed HRMAS NMR as a valuable tool for lead compound identification in the context of fragment-based drug discovery.
Peroxidase 4-Based Enzymatic Synthesis of Stilbene Oligomers in Methyl Jasmonate-Elicited Grapevine Cell Suspensions

tilbenes are specialized metabolites that are particularly abundant in Vitis species. Although the biosynthetic pathways of stilbenes have been well-characterized, the role of specific peroxidases in stilbene oligomerization remains to be investigated. In this study, we used grapevine cell cultures to characterize the functional role of Vitis vinifera peroxidase 4 (VvPRX4) in the production of resveratrol oligomers after elicitation with methyl jasmonate (MeJA). We showed that MeJA triggers the accumulation of t-resveratrol, resveratrol dimers, and predicted resveratrol trimers in culture medium. This accumulation was correlated with upregulation of the PRX4 gene in grapevine cells. Using bacterial crude extracts containing VvPRX4, we demonstrated that VvPRX4 converts t-resveratrol into dimers, t-ε-viniferin into tetramers, and both combined substrates into resveratrol trimers. Additionally, VvPRX4 mediates the formation of glycosylated dimers using t-piceid and t-resveratrol as substrates. These results highlight the functional role of VvPRX4 in stilbene oligomerization in MeJA-elicited grapevine cell cultures.
Exploring the versatility of novel furan-based α,ω-diene carbonate monomers: synthesis, (co-)polymerization, and comparative study

In this work, a novel family of α,ω-diene carbonate monomers was synthesized via the alkoxy carbonylation reaction of bis(hydroxymethyl)furan (BHMF) with dialkyl carbonates (DACs) of varying chain lengths, containing terminal olefins, in the presence of 1,5,7-triazabicyclo[4.4.0]dec-5-ene (TBD). These monomers were then subjected to acyclic diene metathesis (ADMET) polymerization with seven different ruthenium catalysts. The second-generation Hoveyda–Grubbs catalyst proved to be the most effective, yielding furan-based polycarbonates with molecular weights (Mn) up to 19 kDa. The resulting bio-based polymers exhibited thermal degradation temperatures (Td5%) ranging from 156 °C to 244 °C and glass transition temperatures (Tg) from −8 °C to −36 °C. NMR studies confirmed their polymeric structures and provided insights into the polymers organization, which influenced their properties. These novel polycarbonates were then compared to previously reported polyesters and polyethers derived from similar furan-based α,ω-diene monomers. Additionally, for the first time, co-polymerization studies were conducted on three families of furan-based α,ω-diene monomers—ester, ether, and carbonate—revealing the effect of incorporating different functional groups on the properties of the resulting materials. This unprecedented comparison and co-polymerization reactions highlight the versatility of furan-based monomers, but also underscores the possibility to expand their application in creating tailored bio-based materials for diverse applications.
Sustainable and Scalable Enzymatic Production, Structural Elucidation, And Biological Evaluation of Novel Phlorizin Analogues

It is not unusual for naturally occurring compounds to be limited for their use in cosmetics due to their low water solubility. Recently, aiming at accessing novel phlorizin (a glycosylated bioactive recovered from apple tree wood and already used in cosmetics as antioxidant ingredient) analogues, we reported the synthesis of very promising – but low water-soluble – biomass-derived chalcones (CHs) and dihydrochalcones (DHCs) exhibiting antioxidant and anti-tyrosinase activities. Glycosylating bioactive compounds being one of the most common strategies to increase their water solubility, herein we report the enzymatic glycosylation of the CHs mentioned above, as well as DHC using cyclodextrin glycosyltransferases (CGTase), enzymes well-known for catalyzing the selective α(1→4) transglycosylation. Indeed, while most natural glycosides are β-glycosides (such as phlorizin), the selected enzyme produces selectively new α-glycosides, thus expanding their structural diversity. A first step of separation using Centrifugal Partition Chromatography (CPC) led to mono-, di- or triglycosides-enriched fractions, which were then submitted to a comprehensive purification strategy for an in-depth chemical profiling of the synthesized α-glycosides, revealing that the major compounds were glycosylpyranosides. Surprisingly, among the diglycosides characterized, besides the expected maltoside compounds, nigeroside derivatives were also identified in significant amounts, depending on the starting compound structure. Finally, evaluating the antiradical, anti-tyrosinase and antimicrobial activities of the major glycosides revealed them as potential sustainable alternatives to current petro-sourced cosmetic ingredients.
Reversible Photo-Responsive Hydrophobic Coating Synthesized from Lignin-Derivable Molecules on Nanocellulose Films for Packaging Applications

Paper-based packaging can offer a sustainable replacement for plastics. However, paper provides a poor barrier to water, oxygen and moisture. This study presents a novel renewable lignocellulosic composite made from a hydrophobic photo-reversible coating deposited onto a cellulose nanofiber film that has improved barrier properties and can be reprocessed. Diglycerol and lignin-derivable aldehyde were reacted to form a tetra-functional monomer with photo-responsive unsaturated double bonds that can be converted to covalent cyclobutane rings to create reversibly crosslinkable network upon UV-irradiation. The photo-responsive compound was applied as a thin coating of thickness 2.7±0.4 μm over cellulose nanofiber (CNF) films of thickness 80±19 μm. The surface of the coated films became hydrophobic with a contact angle (CA) of 93.1±1.7° and displayed a low water vapour transmission rate (WVTR) of 16±2 g/m2/day vs. 30.7±1.5° CA and 81±11 g/m2/day WVTR for uncoated CNF films. The coated film is also oleophobic, an attractive feature for food packaging applications. The reversible photo-reaction enables the crosslinked covalent network to be broken down to unsaturated double bonds once exposed to a higher-energy UV irradiation, allowing reprocessing and recycling. The novel coating was developed using a sustainable green synthesis method (process simple E factor 0.9).
Investigating the impact of active PHBV films on the nutritional quality of minimally processed apples

The aim of the study was to study the effect of an active film, a blend of poly (3-hydroxybutyrate-co-3-hydroxyvalerate) (PHBV) with a derivative of ferulic acid known as bis-O-dihydroferuloyl-1,4-butanediol (BDF), on the quality decay kinetic of minimally processed apples. Due to its properties, BDF is a promising candidate to serve both as a non-toxic biobased plasticizer and as an active additive, simplifying formulation of active packaging. Molecular modelling studies were conducted to explore the interaction between polyphenol oxidase (PPO) and BDF molecule, with the aim of understanding the mechanism of inhibition.
The apple slices packed in different treatments exhibited an increase in PPO activity; however, the samples packed in active films showed a significantly slower rate of PPO activity (P < 0.05). Almost 50% of the ascorbic acid content degraded in the control samples (4.95–4.97 mg/100 g fruit weight (FW)) at d7 compared with the samples packaged in BDF-releasing films (5.81–6.1 mg/100 g FW) in which the degradation was only 30%. Using molecular modelling, it was observed that BDF (−6.3 kcal/mol) exhibited a stronger interaction with PPO than catechol (−4.5 kcal/mol) in the met and oxy states. BDF-releasing films showed superior preservative potential over the control as BDF competitively inhibits the PPO active site due to π–π stacking between the aromatic cycle of the BDF molecule and the PHE259 and hydrogen bonding with the active site.
Amine-Tolerant E. coli Strains Generated via Adaptive Evolution for Sustainable Synthesis of Chiral Amines

The biocatalytic synthesis of chiral amines from carbonyl compounds and ammonia is a major advance in sustainable synthetic chemistry. Using whole cells for bioamination reactions is advantageous given their low preparation cost and direct applicability; however, amine toxicity limits the reaction when living cells are used. Herein, we adapted Escherichia coli BL21(DE3) cells to grow in the presence of 100 mM hexan-2-amine via directed evolution in continuous culture, obtaining six times more tolerant strains than the wild-type. The adapted strains also displayed superior tolerance for structurally different amines. Coexpression of genes encoding for amine dehydrogenase (AmDH) and formate dehydrogenase activities in the adapted strains enabled the stereoselective bioamination (ee > 99%) of different prochiral ketones with up to 80% conversion at high substrate loading (up to 200 mM) without exogenous cofactor addition. The adapted cells displayed longer survival and higher population density during the reactions. The present biotechnological E. coli system contributes to the development of more robust biocatalysis for amine production.
Charge mediated nano-filtration for recovering sinapic acid from a mustard bran hydrolysate

The recovery of valuable chemicals, such as sinapic acid, from enzymatic hydrolysates is essential to enabling a sustainable biorefinery. In this study, we designed a system to recover sinapic acid produced chemo-enzymatically from waste mustard bran. The process involves sequential separation, beginning with size partitioning using ultrafiltration for enzyme removal and recovery, followed by charge-mediated size partitioning via nanofiltration to isolate sinapic acid from other extracts. Four polyethersulfone (PES) ultrafiltration membranes with molecular weight cut-offs (MWCOs) of 5000 and 10 000 Da and maximum allowable working pressures (MAWPs) of 3 and 10 bar were screened for their effectiveness in removing Bovine Serum Albumin (BSA) as a model compound.
Subsequently, these membranes were applied to recover the feruloyl esterase enzyme. The membrane with an MWCO of 5000 Da and an MAWP of 10 bar achieved 97.93 % enzyme recovery with a permeate flow rate of 31.4 L/h/m2 at 6 bar. Next, we evaluated the effects of zeta potential interactions on the preferential rejection of sinapic acid using various nanofiltration membranes with potentially charged surfaces, including polyimide, silicon-based thin film composite, and polypiperazine amide membranes with MWCOs ranging from 150 to 600 Da. The polypiperazine amide membrane demonstrated the highest recovery of sinapic acid, achieving 86 % recovery from a model solution and 64 % recovery from mustard bran hydrolysate. Compositional analysis of the permeate confirmed that the rejection rate (R) is influenced primarily by the pKa rather than molecular size, following the trend: sinapic acid (pKa = 4.58; 224.2 Da; R = 64.0 %), acetic acid (pKa = 4.76; 60.1 Da; R = 23.8 %), xylose (pKa = 12.15; 150.1 Da; R = 13.7 %), glucose (pKa = 12.28; 180.2 Da; R = 8.7 %), and arabinose (pKa = 12.34; 150.1 Da; R = 8.5 %).
The zeta potential interactions across nanofiltration membranes enhanced sinapic acid recovery from the mustard bran hydrolysate, hence, charge mediation significantly influenced the membrane separation of these complex mixtures with varying pKa values.
Biobased UV Filters and Antioxidants

While solar exposure is essential for human well-being, the adverse effects of excessive UV-A and UV-B radiation, such as sunburns, skin aging, and potential tumor formation, have been extensively studied. Sunscreen stands out as a crucial measure to shield the skin from phototoxic damage caused by UV rays. In addition to synthetic inorganic and organic UV filters, certain natural products - containing aromatic rings, such as flavonoids or polyphenols, or conjugated C=C/C=O/C=N bonds, such as mycosporine-like amino-acids - have the ability to absorb UV radiation, mitigating sunburn and serving as natural UV filters. Furthermore, quite often, these compounds also exhibit antioxidant properties. In addition to these, there are also natural antioxidant molecules that do not absorb UV rays. This chapter provides a non-exhaustive overview of the biobased UV filters and antioxidants, focusing on their origin, chemical structure and production (i.e., extraction from biomass, chemical synthesis, (chemo-)enzymatic synthesis, bioproduction).
Optimizing stilbene recovery from cell cultures media: A comprehensive study of the adsorption process

Stilbenes are of significant interest due to their potential health benefits and applications in pharmaceuticals and nutraceuticals. Traditional extraction methods often involve organic solvents, which pose environmental and safety concerns.This study investigates the extraction of stilbenes (E-resveratrol, labruscol, leachianol, ε-viniferin, and δ-viniferin) from grapevine (Vitis vinifera and Vitis labrusca) cell cultures using adsorption technology. Five food-grade resins (XAD-7, XAD-16, XAD-4, XAD-1180, and FPX-66) were tested for stilbene adsorption. XAD-7 was chosen as the optimum adsorbent, displaying the highest adsorbed quantity (86.94 ± 4.90 mgstilbenes/gdry resin) and desorbed quantity (74.28 ± 0.38 mgstilbenes/gdry resin).
Adsorption kinetics using XAD-7 followed a pseudo-second-order model, with intraparticle diffusion limiting approximately 10 % of total adsorption. Desorption occurs more rapidly than adsorption, achieving equilibrium in about 60 min. Isotherm curves fitted well to a multicomponent Langmuir model, indicating a maximum adsorption capacity of 0.280–0.360 mmolstilbenes/gdry resin, close to the experimental value of 0.271 mmolstilbenes/gdry resin. Stilbene affinity for XAD-7 decreased in the following order: ε-viniferin > (labruscol, E-resveratrol, leachianol) > δ-viniferin. The optimal desorbed quantity of 59.74 ± 0.14 mgstilbenes/gdry resin was achieved with a 70 % ethanol solution and a 160:1 desorption solution-to-adsorbent ratio (v/w). XAD-7 resin coupled with an optimized washing step increased stilbene purity by 4.6 times (from 5.41 ± 0.05 % to 23.19 ± 0.31 % w/w). XAD-7 can be reused for multiple cycles with consistent adsorption capacity and desorption yield, maintaining the same stilbenes purity after 5 cycles.
This study underscores the viability of polymeric resin adsorption as an eco-friendly and efficient method for stilbene extraction from grapevine cell cultures, paving the way for sustainable production processes in the nutraceutical and pharmaceutical industries.
From Vanillin to Concrete Plasticizers: An Innovative Path through ADMET Polymerization

This study describes innovative lignin-based superplasticizers for concrete, focusing on two crucial features: (i) chelation capabilities (e.g., geminal diacids for binding with calcium ions), and (ii) repulsive methoxy polyethylene glycol (MPEG) chains (for better water solubility and particle repulsion). Starting from vanillin, the synthesis of the monomers relies on three key reactions: enzymatic dimerization, Williamson etherification, and Knoevenagel condensation. These monomers are then polymerized through acyclic diene metathesis (ADMET). The most effective polymer, chosen for its efficient polymerization and suitability for large-scale production, is modified to incorporate the desired functionalities and then tested in cement paste, showing deflocculation properties, with an adsorption rate of 42% (for a 35–40% purity range) and improved workability (≈85 Pa vs ≈130 Pa for pure paste). This approach opens up possibilities for further development, such as adjusting the MPEG chain length, MPEG-to-carboxylic acid ratio, molecular weight, and purification steps, to optimize the polymer’s characteristics.
Harnessing the Wharton's jelly membrane osteo-biocompatibility by a tannic acid cross-linking

Decellularized extracellular matrix is a promising material for regenerative medicine applications. Decellularized Wharton's jelly (WJ) is considered as a favorable allograft based material due to its biological properties including antibacterial activities, and immunomodulation. However, the rapid degradation and poor mechanical behavior of WJ derived membranes in biological environment hinders their application in guided bone regeneration. In this study, we have demonstrated that tannic acid (TA), a natural polyphenol, is an efficient cross-linking agent to significantly improve the mechanical properties and the enzymatic stability of WJ membranes. In addition, the post-oxidation of WJ-TA membranes, by sodium periodate, endowed superior biological properties. Indeed, WJ-TA oxidized (WJ-TA-ox) membranes showed antibacterial and antioxidant activities along with a better performance in vitro, improving primary osteoblast and dental pulp stromal cell adhesion and proliferation, and in vivo, increasing the de novo bone formation in a parietal bone defect. These results showed the osteo-biocompatibility and the great potentials of WJ-TA-ox membranes for bone regenerative medicine.
Key-enzymes involved in the biosynthesis of resveratrol-based stilbenes in Vitis spp.: a review

Polyphenols are a large class of plant specialized metabolites with interesting biological properties. Among them, the stilbene phytoalexins are particularly abundant in grapevine gaining considerable applications in the cosmetic and nutraceutical industry. The well-studied stilbene biosynthetic pathway uses phenylalanine to generate resveratrol, the primary stilbene core synthetized in grapevine. A set of enzymes further metabolize resveratrol producing a diversity of stilbenes with different properties, activities and stabilities. In grapevine, 13 enzymes have been identified with the ability to use resveratrol as a substrate, including ten peroxidases, two glycosyltransferases and one O-methyltransferase. Peroxidases and methyltransferases are the most studied enzymes in grapevine, especially under stress conditions while the role of plant laccases and hydroxylases in stilbene metabolism is still poorly described. This article provides an overview of the key enzymes involved in the synthesis of resveratrol-based derivatives in Vitis spp. Perspectives to identify new enzymes are discussed, which could be further used for stilbene bioproduction using biotechnologies.
Evaluation of the antimicrobial and antioxidant properties of synthetic phenolipids

Functionalization of phenolic compounds by lipophilization allowing the synthesis of new compounds with improved biological properties. This study aims to investigate the antimicrobial effects of eight synthesized phenolipids, derived from bioactive coumaric and ferulic acid esters, against Bacillus subtilis, Escherichia coli, and Candida albicans. Antioxidant activity, as well as antimicrobial capacity were evaluated through DPPH assays and classical disc agar diffusion, respectively, concomitantly with the evaluation of cellular viability using flow cytometry assay. Antioxidant activities results showed that ferulic acid esters exhibit higher antiradical activity than coumaric acid esters. Results of agar diffusion assay revealed that, 1-methylpropyl coumarate and 1-methylpropyl ferulate (1-MPF) have an effective antimicrobial activity with Minimum Inhibitory Concentrations (MICs) values between 0.9 – 3.5 mM against all tested microorganisms. Also, flow cytometry showed that 1-MPF and decyl coumarate exhibited significant bactericidal activity (p < 0.05), with almost 63% of dead Bacillus subtilis cells. Compared to the commonly used agar method, flow cytometry proved to be a fast and straightforward analytical tool to assess antimicrobial activity while providing information on inhibition type. These results suggest the applicability of phenolipids as potent lipophilic bioactive molecules to protect food products and cosmetic formulations from oxidative stress and microbial spoilage.
Controlled Enzymatic Synthesis of Polyesters Based on a Cellulose-derived Triol Monomer: A Design of Experiment approach

Regioselective enzymatic polycondensation of the bio-based cellulose derived polyol, Triol-citro, and dimethyl adipate using Candida antarctica Lipase B (CaLB) was investigated. A Design of Experiment approach with MODDE® Pro 13 was used to determine important factors in the branching behavior of this polymer, and reactant ratio, temperature, reaction time and enzyme wt% were the studied factors. Multifunctional polyesters with pendant hydroxyl groups were synthesized and fully characterized using 2D NMR techniques to determine degree of branching. Branching was minimal, with a maximum of 16% observed, and monomer ratio, temperature and reaction time were all determined to be significant factors. In this work, Mn of up to 13 kDa were achieved, while maintaining degree of branching below 15%, resulting in a linear polyester with the potential to be further functionalized.
Investigation of ferulic acid recovery from enzymatic hydrolysate of wheat bran using various solvents and liquid-liquid extraction assisted by membrane contactor

Ferulic acid (FA) is the main phenolic compound in wheat bran. Its antioxidant and antibacterial properties make it a valuable product in various field. This study investigates the recovery of FA from an enzymatic hydrolysate of wheat bran via a liquid–liquid extraction (LLE) assisted by membrane contactor (MC).
Initially, three alcohols (oleyl alcohol, octan-1-ol, decan-1-ol), two esters (1-octyl acetate and ethyl acetate), and one ketone (methyl isobutyl ketone) were examined for FA recovery from a binary solution with varying pH and initial FA concentrations. Subsequently, the LLE assisted by MC from the enzymatic hydrolysate at both natural pH (5.5) and adjusted pH (4) was studied. The findings indicate that, at pH 4, all the solvents extract over 88–97 % of FA. At pH 5, 6, and 7, only oleyl alcohol and 1-octyl acetate achieve extractions exceeding 82–89 %. The examination of the initial FA concentration ranging from 50 to 250 mg/L showed no significant impact on FA recovery, as all solvents permitted extraction of more than 92 %.
The results of the LLE assisted by MC of FA from the enzymatic hydrolysate have shown that initial pH and solvent viscosity play a crucial role in both the kinetics and the maximum recovery yield of FA. Specifically, at pH 4, extraction kinetics are significantly faster, resulting in a potential yield in excess of 97 %. However, higher solvent viscosity decreases extraction kinetics, reducing the mass transfer coefficient.
The use of MC proves advantageous in preventing the formation of emulsions, particularly when long-chain alcohols and esters are involved in the process. The obtained results enabled proposing a comprehensive solution to recover FA from biomass, a crucial step in optimizing the utilization of natural phenolic compounds for potential applications across various industries.
Green synthesis of (R)-3-hydroxy-decanoic acid and analogues from Levoglucosenone: A novel access to the fatty acid moiety of rhamnolipids

Exhibiting outstanding biosurfactant properties, rhamnolipids (RLs) are highly valuable molecules in the cosmetic, pharmaceutic and agricultural sectors. In the latter, they are used to artificially stimulate natural immune system of crops (also known as elicitation). To decipher their mechanisms of action, readily access natural RLs, and design novel potent elicitors, a straightforward and green access is needed. Herein, starting from cellulose-derived levoglucosenone, we propose an efficient seven-step synthetic pathway to prepare enantiopure (R)-3-hydroxy-fatty acid chains present in RLs with Michael addition, Baeyer-Villiger oxidation, Bernet-Vasella reaction and cross metathesis homologation as key steps (global yield ranging from 24% to 36%).
Deciphering the enzymatic grafting of vanillin onto lignosulfonate for the production of versatile aldehydes-bearing biomaterials

Modification of lignin plays a crucial role in extending its applications. While chemical functionalization has been extensively applied, exploring the enzyme-catalyzed approach for grafting phenolic molecules presents a promising avenue. Herein, we investigate the controlled laccase-mediated grafting of vanillin onto lignosulfonates (LS) as a sustainable approach to introduce aldehydes into LS, paving the way for further (bio)chemical functionalizations (e.g., reductive amination and Knoevenagel-Doebner condensations). The resulting vanillin-grafted LS is comprehensively characterized (HPLC, SEC, Pyrolysis-GC/MS, FTIR). The study reveals four key steps in the grafting process: (i) vanillin acts as a mediator, generating the phenoxyl radical that initiates LS oxidation, (ii) the oxidation leads to depolymerization of LS, resulting in a decrease in molecular weight, (iii) rearrangement in the vanillin-grafted LS, evidenced by the replacement of labile bonds by stronger 5–5 bonds that resist to pyrolysis, and (iv) if the reaction is prolonged after complete consumption of vanillin, condensation of the vanillin-grafted LS occurs, leading to a significant increase in molecular weight. This study provides valuable insights on the behavior of vanillin and LS throughout the process and allows to identify the optimal reaction conditions, thereby enhancing the production of vanillin-grafted LS for its subsequent functionalization.
An expeditive and green chemo-enzymatic route to diester sinapoyl-l-malate analogues: sustainable bioinspired and biosourced UV filters and molecular heaters

Sinapoyl malate, naturally present in plants, has proved to be an exceptional UV filter and molecular heater for plants. Although there are nowadays industrially relevant sustainable synthetic routes to sinapoyl malate, its incorporation into certain cosmetic formulations, as well as its adsorption on plant leaves, is limited by its hydrophilicity. To overcome these obstacles, it is important to find a way to effectively control the hydrophilic–lipophilic balance of sinapoyl malate to make it readily compatible with the cosmetic formulations and stick on the waxy cuticle of leaves. To this end, herein, we describe a highly regioselective chemo-enzymatic synthesis of sinapoyl malate analogues possessing fatty aliphatic chains of variable length, enabling the lipophilicity of the compounds to be modulated. The potential toxicity (i.e., mutagenicity, carcinogenicity, endocrine disruption, acute and repeated-dose toxicity), bioaccumulation, persistence and biodegradability potential of these new analogues were evaluated in silico, along with the study of their transient absorption spectroscopy, their photostability as well as their photodegradation products.
Novel Biobased Multifunctional Emollients for Cosmetic Applications: Toward the Ingredient-List Reduction

The use of several ingredients in cosmetic formulations can often result in long ingredient lists, which can be daunting for consumers. While each of these particular ingredients serves a purpose, some are petroleum-based and may have adverse effects on the environment and human health. Ferulic acid, a p-hydroxycinnamic acid present in numerous agro-industrial byproducts, exhibits antimicrobial, antioxidant, and UV-filtering properties. In this work, ferulic acid was functionalized through chemoenzymatic reaction steps (80 to 93% isolated yields) applying green chemistry principles, by using various natural fatty alcohols. The resulting compounds have demonstrated good emollient properties through physicochemical and spreading evaluations. Two green metrics (Mass Intensity and Ecoscale) were used to assess the synthesis of these novel emollients, which were found to have a very low environmental impact. The findings of this study could provide a novel solution for multifunctional, biobased ingredients in cosmetic formulations while reducing the environmental impact of the products.
Can synthetic biology really empower microbial biopolymers as efficient food contact materials?

This opinion paper explores the potential of integrating synthetic biology into microbial polymers to produce tailored biopolymers for food packaging applications. Synthetic biology has shown precise control over metabolic machinery, enabling the manipulation of pathways involved in microbial biopolymer production. However, there is limited literature available on utilizing the same pathways for designing tailored biopolymers suitable as efficient food contact materials. This is primarily due to the regulatory status of microbial polymers as determined by food safety authorities. One possible solution is to leverage synthetic biology tools by adopting safety assessment protocols established within the regulatory framework. By considering the advantages of synthetic biology-driven microbial polymers, this innovative approach has the potential, not only to replace conventional methods but also to provide additional value by addressing environmental concerns associated with traditional food packaging.
Furandicarboxylate Polyesters: A Comprehensive ADMET Study of a Novel Class of Furan-Based α,ω-Diene Monomers

The present research article delves into the preparation of a new class of bio-based polyesters from α,ω-diene furandicarboxylate monomers. In particular, it exploits the use of acyclic diene metathesis polymerisation (ADMET) on 2,5-furandicarboxylic acid (FDCA)-derived compounds. First, a library of furan-based α,ω-diene monomers was prepared via acid- or base-catalyzed transesterification of 2,5-furandicarboxylic acid dimethyl ester (FDME) with commercially available alcohols incorporating terminal olefins, i. e., allyl alcohol, but-3-en-1-ol, hex-5-en-1-ol and dec-9-en-1-ol. Then, the novel monomers were subjected to ADMET polymerisation employing different catalysts and reaction conditions. Interestingly, first-generation Grubbs catalyst was found to be the best promoter for ADMET polymerisation. This catalyst allowed the preparation of a new family of bio-based polyesters with molecular weights up to 26.4 kDa, with good thermal stability, and adaptable cis-trans conformations. Results also revealed that the monomer structure had a direct impact on the polymerisation efficiency and the resulting thermal properties. The effect of green bio-based solvents such as Cyrene™, dimethyl isosorbide (DMI) and γ-valerolactone (GVL) on the polymerisation process was also studied. Data collected showed that the solvent concentration influenced both the yield and length of polymers formed. Furthermore, some co-polymerisation experiments were conducted; the successful integration of different monomers in the resulting copolymer was shown to affect the glass transition temperature (Tg) of the resulting materials.
Liquid-liquid extraction of sinapic acid from a mustard seed by-product using a hollow fiber membrane contactor

This study focuses on the recovery of sinapic acid using liquid–liquid extraction (LLE) assisted by a hollow fiber membrane contactor (HFMC) from an aqueous feed obtained through the hydrolysis of mustard bran. The hydrolyste contains 230 ± 36 mg/L of sinapic acid, with a natural pH of 4. A screening was performed with solvents of different chemical nature (alcohol, ester, ketone, ether, cyclic ether). Data showed that all the solvents tested gave an extraction efficiency of more than 80 % for pH < 5, whereas the initial concentration of sinapic acid in the aqueous feed has little impact on the extraction efficiency. Four of the solvents tested were selected for use in the HFMC: two volatile (CPME, MIBK) and two non-volatile (octanol, octyl acetate). The solubility of the volatile solvents in the feed phase was found to be an important factor to consider in evaluating the HFMC (2.6 ± 0.5 % and 1.07 ± 0.05 % v/v with MIBK and CPME, respectively). Mass transfer coefficients with volatile solvents (25 ± 1 x10-6 and 15.3 ± 0.5 x10-6 m/s for MIBK and CPME, respectively) exceeded those of non-volatile solvents (4.1 ± 0.2 x10-6 and 4.5 ± 0.5 x10-6 for octanol and octyl acetate, respectively) by 4- to 6-fold. Extraction was intensified by increasing the initial concentration of sinapic acid in the feed phase and by increasing the feed-to-solvent ratio. CPME demonstrated optimal recovery efficiency at a phase ratio of 8:1 (v/v), yielding 0.9 g of sinapic acid per liter of CPME used.
Sustainable mechanosynthesis of diamide tetraols monomers and their enzymatic polymerization

A novel method for synthesizing biobased diamide tetraol derivatives through mechanochemical processes is presented in this study. The key component used in the synthesis is (S)-γ-hydroxymethyl-γ-butyrolactone (2H-HBO), a cellulose-based lactone derived from levoglucosenone, combined with various linear diamines. The use of planetary ball milling in the presence of a small excess of diamine was found to be crucial for achieving complete conversion of 2H-HBO and the selective formation of diamide tetraol derivatives. The optimized parameters established for the reaction of 2H-HBO using diaminohexane were applied to biobased, non-toxic, and biodegradable diamines such as spermidine, spermine, and 4,9-dioxa-dodecanediamine. This resulted in high conversions and good yields of diamide tetraol derivatives. The scalability of the process was demonstrated by transposing the reaction from 100 mg to 2 g, with improved conversions obtained at a larger scale. The greenness of the procedure was assessed using the E-factor and EcoScale, showing low waste generation and acceptable to excellent reaction conditions. In addition, enzymatic polymerization of diamide tetraol derivatives using CAL-B (Candida antarctica lipase B) as a biocatalyst was explored. Successful polymerization of monomers obtained from hexamethylene diamine and 4,9-dioxa-dodecandiamine was achieved, providing insights into the effect of enzyme loading and monomer ratios on the molecular weight of the resulting polymers. Despite challenges with certain monomers containing amine groups, this work offers a promising approach for producing multifunctional biobased polymers.
Biobased Polyethers via Acyclic Diene Metathesis Polymerization of α,ω-Diene Furanics

A new class of furanic α,ω-dienes was synthesized by using cellulose-derived 2,5-bis(hydroxymethyl)furan as a renewable starting material. The ability of these monomers to undergo acyclic diene metathesis polymerization was investigated under various reaction conditions, including type of metathesis catalyst and catalyst loading. The resulting biobased polyethers were characterized through high-performance size exclusion chromatography, differential scanning calorimetry, and thermal gravimetric analysis. The novel polymers showed molecular weights up to 43 kDa and exhibited good thermal stability (Td5% up to 301 °C) and low glass-transition temperatures (−67 °C < Tg < −24 °C). Polymerization reactions were also conducted employing selected green solvents (Cyrene, dimethyl isosorbide, and γ-valerolactone), and the results were compared to those of the solvent-free procedure. Finally, in order to increase the Tg values of the polyethers, copolymerization experiments were performed employing the best performing furanic α,ω-diene as well as a biobased aromatic monomer derived from syringaresinol.
Green Synthesis of UV-Reactive Polycarbonates from Levoglucosenone And 5-Hydroxymethyl Furfural

This study focuses on the synthesis of fully renewable polycarbonates (PCs) starting from cellulose-based platform molecules levoglucosenone (LGO) and 2,5-bis(hydroxymethyl)furan (BHMF). These unique bio-based PCs were obtained through the reaction of a citronellol-containing triol (Triol-citro) derived from LGO, with a dimethyl carbonate derivative of BHMF (BHMF-DC). Solvent-free polymerizations were targeted to minimize waste generation and promote an eco-friendly approach with a favorable environmental factor (E-factor). The choice of metal catalyst during polymerization significantly influenced the polymer properties, resulting in high molecular weight (up to 755 kDa) when Na2CO3 was employed as inexpensive catalyst. Characterization using Nuclear Magnetic Resonance (NMR) confirmed the successful incorporation of the furan ring and the retention of the terminal double bond of citronellol pendant chain. Furthermore, under ultraviolet (UV) irradiation, the presence of both citronellol and furanic moieties induced singular structural changes, triggering the formation of three distinct structures within the polymer network, a phenomenon herein observed for the first time in this type of polymers. These findings pave the way to new functional materials prepared from renewable monomers with tunable properties.
Sustainability Appraisal of Polymer Chemistry Using E-Factor: Opportunities, Limitations and Future Directions

Sustainability assessment of polymer production processes is of utmost importance to evaluate their environmental, social and economic impact, but it remains poorly studied. This chapter aims to raise the awareness of researchers and readers in academia, industry and civil society about this issue and some of the easy and straightforward methods to assess the greenness of polymers. To that end, it begins with an overview of polymer waste reduction, followed by the main methods of reducing the waste generated. It then describes in more details how readily available green metrics, such as environmental factor (E-factor), can help to assess manufacturing processes and polymer products, and identify areas where improvements can be made. Then, it describes methods that can be used in conjunction with E-factor to better assess the sustainability of a production process, while also showing the limitations/challenges linked to these methods. The main approaches to polymer development from biomass are presented, followed by a focus on E-factor calculations of examples of the widely used lignin-derived monomers and polymers (e.g., vanillin), as well as the rapidly evolving field of levoglucosenone-derived monomers and polymers. Future directions for improving the field of (sustainable) polymer chemistry is also provided.
Levoglucosenone to 3D-Printed Green Materials: Synthesizing Sustainable and Tunable Monomers for Eco-Friendly Photo-curing

3D-printing technologies for polymeric formulations are experiencing a huge development due to the complex and specific geometries that can be covered employing additive manufacturing. However, to ensure sustainable growth, it is essential to replace the currently used fossil-based resins with new bio-sourced alternatives. In this study, tunable bis-allylated compounds were efficiently synthesized from cellulose-derived levoglucosenone via a chemo-enzymatic pathway whom greenness has been assessed by E-factor and Eco-Scale. Subsequently, photocuring was employed as an eco-friendly process to polymerize these compounds with a trifunctional thiol using thiol-ene click chemistry. Real-time techniques such as FT-IR, photo-DSC, and photo-rheology were employed to extensively characterize the UV-process. The resulting thermosets were also subjected to a thorough analysis, covering their thermal-mechanical properties and degradation. Owing to the exceptional reactivity of this thiol-ene system, 3-D printed materials were achieved with remarkable precision.
Chemo-Enzymatic Synthesis and Biological Assessment of p-Coumarate Fatty Esters: New Antifungal Agents for Potential Plant Protection

One trend in agriculture is the replacement of classical pesticides with more ecofriendly solutions, such as elicitation, which is a promising approach consisting of stimulating the natural immune system of a plant to improve its resistance to pathogens. In this fashion, a library of p-coumaric-based compounds were synthesized in accordance with as many principles of green chemistry as possible. Then, these molecules were tested for (1) the direct inhibition of mycelium growth of two pathogens, Botrytis cinerea and Sclerotinia sclerotiorum, and (2) plasma membrane destabilization in Arabidopsis and rapeseed. Finally, the protective effect was evaluated on an Arabidopsis/B. cinerea pathosystem. Total inhibition of the growth of both fungi could be achieved, and significant ion leakage was observed using dihydroxylated fatty p-coumarate esters. A direct effect on plants was also recorded as a ca. three-fold reduction in the necrosis area.
Combining Laccase-Mediated Dimerization of Resveratrol and Centrifugal Partition Chromatography

Resveratrol dimers are of great interest for pharmaceutical and cosmetic applications. Nevertheless, the yield of their bioproduction is limited by both the competition between the possible radical–radical coupling pathways and complex isolation procedures. Alternative organic synthesis methods do not afford higher yields. Although enzymatic routes can provide dimers in one step from resveratrol, biocatalysis optimization is required to improve yields and orient radical–radical coupling selectivity toward a specific resveratrol dimer, E-labruscol herein.
After a rapid study of the relative importance of the biocatalysis parameters, a design of experiments was implemented to produce E-labruscol in high yield by laccase-mediated dimerization of resveratrol. E-labruscol and δ-viniferin were identified and isolated by flash chromatography as major products in 21 and 52% yields, respectively. As an alternative to purification on silica gel, efficient separation of the aforementioned compounds was achieved by centrifugal partition chromatography (CPC).
This technology provided δ-viniferin in 63.1% yield (90% purity) and labruscol isomers in 20.4% yield with a purity of 95% after a CPC polishing step, but it also revealed the presence of E-labruscol diastereomers, leachianol F and leachianol G, as major reaction products, as well as less abundant products: pallidol, Z-labruscol, ε-viniferin, and two new resveratrol dimers named iso-δ-viniferin and iso-ε-viniferin.
Enzymatic extraction of ferulic acid from brewer’s spent grain: Effect of physical pretreatments and optimization using design of experiments

Brewers' grains (BSG), the main waste product of the beer industry, are widely available and rich in fiber and bioactive compounds. Ferulic acid (FA) is the main phenolic compound in BSG, it has antioxidant and antibacterial properties that make it a valuable product for cosmetic, food and pharmaceutical industries. Alkaline hydrolysis is the common technology for extracting FA from biomass, this technology needs to be substituted as it is non-selective and requires harsh conditions making purification more complicated and expensive. This research work presents enzymatic hydrolysis as a green alternative for FA extraction. Five commercial enzymes were screened and compared for their hydrolytic efficiency to release FA. Prior to the enzymatic hydrolysis, autoclave was selected as the most effective pretreatment. Depol 740L was selected as the desired enzyme based on its high feruloyl esterase activity (0.4 U/mL). The enzymatic extraction parameters (pH, temperature and enzyme dosage) were optimized using response surface methodology. The highest FA recovery, 1.06 ± 0.01 mg/g dry weight (43.13% in comparison with the alkaline hydrolysis), could be achieved at pH 5.27; temperature 60 °C and 1.72% enzyme. The optimal extraction conditions were found to be sufficient within 22 h, as determined by a kinetic study.
Optimization of DIC-Tripolium Ecofriendly Extraction Process: Recovery of Hesperidin from Orange Byproducts, Antioxidant and α-Amylase Inhibition of Extracts
This study aimed to investigate the effect of an innovative ecofriendly process—instant controlled pressure drop technology, also known as “détente instantanée contrôlée” or DIC—coupled with Tripolium extraction (DIC-Tripolium), on the hesperidin recovery, and antioxidant and antidiabetic activities of orange byproduct extracts. A DIC pretreatment was applied to partially dried orange byproducts (~16% wet basis). A central composite rotatable design (CCRD), composed of 13 experimental trials (four factorial points, four-star points, and five repetitions for the central point), was followed by a Tripolium process consisting of successive intermittent extraction periods using ethanol/water solvent at 20 ± 1 °C, 5 kPa for 5 min and m/v ratio = 5 g/50 mL. The DIC pretreatment, coupled with the Tripolium process, increased the extractability of hesperidin (from 1.55- to 4.67-fold compared to untreated DIC orange byproducts). The radical scavenging activities of the extracts were also enhanced or preserved in different DIC–Tripolium extracts. The α-Amylase inhibition percentage varied between 55.6 ± 0.02 and 88.30 ± 0.01% according to DIC–Tripolium conditions. The multi-criteria optimized condition of DIC–Tripolium extraction, allowing for the maximization of the hesperidin content, radical scavenging activities, iron chelating activity, and α-amylase inhibition of extracts, corresponds to a DIC saturated steam pressure of 599.4 kPa and a DIC pretreatment time of 38 s.
Membrane contactors-assisted liquid-liquid extraction of biomolecules from biorefinery liquid streams: A case study on organic acids

The use of membrane contactors (MC) for the recovery of biomolecules in biorefinery processes has become increasingly popular thanks to their desirable properties such as robustness, large surface area, modularity and flexibility, as well as their non-dispersive nature. This review article provides a recent comprehensive and critical look into the recent progress made in the application of MC for the recovery of biomolecules such as aroma compounds (acetophenone, 2-phenylethanol, etc.), butanol, antibiotics, and organic acids from aqueous media and fermentation broths. Although some previous reviews have discussed the design and operation of membrane contactors for applications such as dissolved gases management and CO2 capture, this review focuses on the liquid-liquid extraction of biomolecules from biorefinery liquid streams. It includes a detailed discussion of the technical characteristics of MC and their applications for liquid-liquid extraction of organic molecules from bioconversion and liquid media. A focus is then put on the use of MC for the extraction of organic acids, looking at the effects of operating conditions, extracting phase, and feed phase on the extraction process, as well as proposing back-extraction of organic acids by MC. Some of the challenges and limitations currently associated with these applications are highlighted.
Microfluidics for Polymer Microparticles: Opinion on Sustainability and Scalability

The microfluidic production of simple (microspheres) and core–shell (microcapsules) polymer microparticles, often called microencapsulation, has been the scope of several research works since the 1980s. It is a fast, thrifty, and efficient process because of its controlled properties, tuneability, and yield, which can reach 100%. However, the question of its greenness, sustainability, and scalability remains unclear, and more awareness/education is required in this field. The sustainability of production processes using microfluidic techniques can be realized/discussed based on three pillars: (i) waste generation, (ii) the solvents employed, and (iii) raw materials. On the other hand, although the scaling-up of these processes was reported on in several papers as procedures in which hundreds or thousands of microfluidic chips are set in parallel, the sustainability of this scale-up has not been addressed to our knowledge. This opinion paper highlights the advantages of microfluidic encapsulation processes, their greenness according to the above-mentioned pillars, (i–iii) and the necessary considerations to scale them up while preserving their sustainability.
Straightforward sustainable synthesis of novel non-endocrine disruptive bio-based organic UV-B filters with antimicrobial activity

With an increasing demand for safe and natural products from both industries and consumers, paired with the recent ban of decried molecules (i.e. octinoxate, avobenzone or octocrylene) due to their high negative impact on humans and the environment (i.e. endocrine disruption, coral bleaching), safe bio-based alternatives are a necessary and promising surrogate to substitute current commercialized petroleum-based UV filters. In this context, a class of bio-based molecules, displaying interesting UV-B filtering properties and great photostability were developed from furfural and 5-hydroxymethylfurfural (HMF), using the Knoevenagel condensation with a set of green conditions to minimize the impact on environment. Furthermore, those furfural- and HMF-based molecules demonstrated antimicrobial properties as secondary activity, highly sought by industries. Some furan derivatives being recognized to exhibit toxicological risks, in silico and in vitro assays were conducted and demonstrated the absence of endocrine disruption activity for these new molecules.
Combining the Power of Biocatalysis and Membrane-Based Purification To Access NADP+

In this study, using a model solution corresponding to the final medium composition of the NADP+ enzymatic production, we present for the first time a sustainable and simple alternative membrane-based filtration process that readily provides NADP+ in high purity. A membrane selection was first performed, and the GE membrane (Suez Water Technologies & Solutions (USA)) was shown to provide the best NADP+ retention rate >80% at 4 bar. An enzymatic strategy based on the addition of a commercial ATP diphosphohydrolase (apyrase from potatoes) to the model solution significantly simplified the composition of the medium, resulting in a very good discrimination profile between NADP+ and AMP retention (69.3% gap) on the one side, and NADP+ and adenine (87.5% gap) on the other. These data allowed to predict a profile of purity and loss of NADP+ as a function of diafiltration volume (DV). According to these predictions, a >90% purity could be achieved after only 4 DV, demonstrating that this membrane-based purification method achieves a very high purity rate of NADP+ while being competitive compared to the other conventional methods currently used.
Intensifying Effect of Instant Controlled Pressure Drop (DIC) Pre-Treatment on Hesperidin Recovery from Orange Byproducts: In Vitro Antioxidant and Antidiabetic Activities of the Extracts

The orange byproduct is a widely accessible and valuable source of functional phenolic compounds, particularly hesperidin. Hesperidin extraction remains a challenging phase in its valorization chain due to its low solubility and limited extractability in solvents. This work aims to examine the effect of conventional solvent extraction (CSE) compared to emerging and innovative extraction methods: accelerated solvent extraction (ASE) and ultrasound-assisted extraction (UAE) when applied with or without a pretreatment process of instant controlled pressure drop (DIC) to intensify extraction, antioxidant, and antidiabetic activities. The total phenols, flavonoids, hesperidin contents, radical scavenging activities, iron chelating activity, and in vitro α-amylase inhibition of the extracts were determined for CSE (80%, 70 °C), UAE (ethanol 80%, 70 °C, 200 W), and ASE (ethanol 60%, 100 °C, 100 bars) with or without DIC pretreatment (pressure = 0.4 MPa, total thermal time = 30 s). The hesperidin amounts obtained were 0.771 ± 0.008 g/100 g DM, 0.823 ± 0.054 g/100 g DM, and 1.368 ± 0.058 g/100 g DM, for CSE, UAE, and ASE, respectively. DIC pretreatment of orange byproducts increased hesperidin recovery by 67%, 25.6%, and 141% for DIC-CSE, DIC-UAE, and DIC-ASE, respectively. The DPPH and ABTS radical scavenging and iron chelating activities of extracts were also significantly enhanced, and the in vitro antidiabetic activity of extracts was preserved.
Photo-responsive lignin fragment-based polymers as switchable adhesives

Easily detachable and reusable adhesives are attractive as single-use adhesive replacements to reduce waste and promote reuse, recycling, or even upcycling options. Lignin, the second most abundant polymer and a byproduct of the paper-pulp industry, was utilized to design a novel, highly tunable reversible polymer adhesive. The approach adopted was to take advantage of the photo-responsive property of the α,β-unsaturated ester moiety of the p-hydroxycinnamic acid structure synthesized in this work using lignin-oxidation compounds and modified to attain reversible adhesion switching. The reversibility is achieved by the exposure of UV light that cleaves the covalent cyclobutane rings originally formed from the α,β-unsaturated bond of the ester, which softens the material and makes it easily separable. The original polymer structure can be established again by recrosslinking to offer reworkability. The design of experiments (DoE) method was introduced to optimize the significant variables to achieve optimum lap shear strength for the adhesive. The effect of various structural aspects shows a high tunability of the structure to meet the property requirements. The design strategy of the polymer adhesive from renewable resources, along with the structure–property analysis mechanisms described in this work, can be implemented to engineer new bio-based and reusable adhesives.
Improvement of Sinapine Extraction from Mustard Seed Meal by Application of Emerging Technologies

Sinapine is a phenolic compound found in mustard (Brassica juncea) seed meal. It has numerous beneficial properties such as antitumor, neuroprotective, antioxidant, and hepatoprotective effects, making its extraction relevant. In this study, the extraction of sinapine was investigated using three methods: (i) from a mustard seed meal defatted by a supercritical CO2 (SC-CO2) pretreatment, (ii) by the implementation of high-voltage electrical discharges (HVEDs), (iii) and by the use of ultrasound. The use of SC-CO2 pretreatment resulted in a dual effect on the valorization of mustard seed meal, acting as a green solvent for oil recovery and increasing the yield of extracted sinapine by 24.4% compared to the control. The combination of ultrasound and SC-CO2 pretreatment further increased the yield of sinapine by 32%. The optimal conditions for ultrasound-assisted extraction, determined through a response surface methodology, are a temperature of 75 °C, 70% ethanol, and 100% ultrasound amplitude, resulting in a sinapine yield of 6.90 ± 0.03 mg/g dry matter. In contrast, the application of HVEDs in the extraction process was not optimized, as it led to the degradation of sinapine even at low-energy inputs.
Online Microfluidic Production of Sustainable Cyrene™-Derived Porous Microparticles

The use of sustainable raw materials is now a necessity in all industries, including the production of porous microparticles. Cyrene™ is a cellulose-derived compound that is readily prepared through the reduction of the α,β-unsaturation of levoglucosenone (LGO)—a wood-based platform molecule. In this work, the importance of Cyrene™ as a potential bio-based molecule to produce sustainable porous microparticles is demonstrated. First, a methacrylic derivative of Cyrene™ (m-Cyrene) was synthesized. A microfluidic co-flow device was then established to produce m-Cyrene-based oil-in-water (O/W) controlled-size emulsions and to polymerize them by ultraviolet (UV) radiation in a vial. The continuous phase was a sodium dodecyl sulfate aqueous solution, and the dispersed phase was a mixture of m-Cyrene with methacrylic anhydride (MAN) at two different mass concentrations (i.e., 1 wt.% MAN and 92 wt.% MAN) and 2,2-dimethoxy-2-phenylacetophenone (DMPA) as a photoinitiator. The process used the lowest possible quantity of raw materials and avoided excessive purifications to produce homogeneous porous m-Cyrene-MAN microparticles. The controlled size and homogeneous size distribution of the produced polymer microparticles were confirmed by scanning electron microscope (SEM) images. The 3D microstructure as well as the porosity were determined using X-ray microtomography. The high-resolution 3D images produced indicate that the pores of the microparticles are homogeneous and that their porosity is controllable through the concentration of MAN in the monomer mixture (porosity of 30% for a 1 wt.% MAN ratio and 2% for a 92 wt.% MAN ratio). Such porosity control is very important for future potential encapsulation processes that require precise release control. Keywords: sustainable production; size control; Cyrene™; microtomography; porosity
Fire testing and mechanical properties of neat and elastomeric polylactic acid composites reinforced with raw and enzymatically treated hemp fibers

A new class of biobased composites with tailorable mechanical properties made of natural fibers, polylactic acid, and ferulic acid derivatives (FAD) is studied. FAD was used to develop composites with elastomeric properties like improved elongation at break and highly reversible deformation upon elongation. Composites were prepared using raw and enzymatically treated hemp fibers. The fibers were defibrillated due to the enzymatic treatment increasing their aspect ratio. The composites were characterized by their mechanical properties and their reaction to fire. No significant change in the dispersion of the fibers in the composites was reported. Homogenously dispersed crystallites of FAD were observed by scanning electron microscopy in the PLA matrix and at the interface between the PLA and the fibers, where they are suspected to increase the free volume in correlation with a decrease in mechanical properties following the increase in the aspect ratio of the fibers. FAD also degraded the reaction to fire of the material with an increase in 10% of the peak of Heat Release Rate (pHRR) in comparison to neat PLA. It also increased the charring residue up to 3 wt.%. A synergistic effect between FAD and the lignin increasing the charring residue is also reported.
Effect of ferulic acid derivative concentration on the release kinetics, antioxidant capacity, and thermal behaviour of different polymeric films

Ferulic acid displays poor thermal resistance during extrusion and compression moulding, slow 2,2-diphenyl-1-picrylhydrazyl (DPPH) reaction kinetics, and undetected release from polylactide (PLA) and polyhydroxyalkanoates (PHA)-based films into polar mediums. Thus, in this study, a ferulic acid derivative Bis-O-dihydroferuloyl-1,4-butanediol (BDF) was used as an active additive (up to 40 w%) in PLA, poly(3-hydroxybutyrate) (PHB), and poly(3-hydroxybutyrate-co-3-hydroxyvalerate) (PHBV) matrices to produce blends by extrusion.
These blends were then used to prepare films by solvent casting. The BDF displayed good stability with 86-93% retention. The release kinetics in Food Simulant A revealed higher BDF release amounts (1.16-3.2%) for PHA-based films as compared to PLA. The BDF displayed faster DPPH reaction kinetics as compared to ferulic acid. The PHA-based films containing BDF displayed > 80% of DPPH inhibition. The growth of crystals inside polymer matrix had a nucleation effect which reduced the glass transition temperature of the films.
Levoglucosenone-derived synthesis of bio-based solvents and polyesters

Polyesters are important materials with a wide range of applications, but there has been increasing concern over their sustainability. One example is the need for safer, bio-derived solvents to replace those currently in use for the polymer’s synthesis and processing. In this work, several variants of the bio-based cellulose/levoglucosenone derived solvent Cyrene, namely the ketal derivatives dioxolane Cygnet, dioxane Cygnet and dioxepane Cygnet were synthesized and tested as media for enzymatic polycondensation reactions using bio-based building blocks. Dioxolane Cygnet and dioxepane Cygnet were found to be suitable solvents for enzymatic polycondensation reactions, with dioxolane Cygnet being the preferred solvent, yielding polymers with a Mn >22 kDa. In addition, these solvents were tested in the biocatalyzed synthesis of levoglucosenone-based polyesters. The alternative solvents gave superior yields to those previously observed, demonstrating the versatility of these solvents in enzymatic polycondensation reactions, representing the first synthetic polymer-solvent system fully derived from cellulose.
Optimization of the supercritical extraction of rosmarinic acid from clary sage residue and the antioxidant activity of the extracts

This study focuses on the extraction of bioactive compounds from clary sage (Salvia sclarea L.) distillation residue with carbon dioxide under supercritical conditions. The target component is rosmarinic acid, a naturally occurring phenolic compound with strong antioxidant properties. Response surface methodology was applied to optimize the operating temperature, pressure and the co-solvent composition in the range of 40–100 °C, 100–600 bar, and 0–100 % ethanol in water (v/v), respectively.
The quantification of rosmarinic acid was performed using HPLC and the antioxidant activity of extracts was measured using DPPH assay. Results showed that the yield of extraction of rosmarinic acid and the antioxidant activity of the extracts varied significantly at each extraction condition. Based on the optimization study, the optimum pressure, temperature and the composition of the co-solvent were 100 bar, 65 °C and 35 % ethanol, respectively, with more than 8 mg/g of rosmarinic acid concentration obtained.
Total syntheses and production pathways of Levoglucosenone, a highly valuable chiral chemical platform for the chemical industry

Levoglucosenone (LGO) - which possesses two chiral centers, a ketal and one α,β-unsaturated ketone moieties - is a high value renewable chiral building block that can be used for the production of a wide range of bio-based fine chemicals and polymers, as well as green solvents. This mini-review illustrates the different main strategies that have been developed to produce LGO from different starting materials such as lignocellulosic biomass, pure cellulose, sugars and non-sugar compounds.
Aliphatic-Aromatic Polyesters from Naturally Occurring Sinapic Acid through Acyclic-Diene Metathesis Polymerization in Bulk and Green Solvent Cyrene

Green synthesis of renewable alternatives to fossil fuel-based (macro)molecules/polymers is more than ever a necessity. We recently developed a sustainable pathway to produce 6-hydroxy-5,7-dimethoxy-2-naphthoic acid (DMNA), which resembles the fossil-derived 6-hydroxy-2-naphthoic acid, from sinapic acid. To investigate the potential of DMNA as a building block for polymer syntheses, three novel DMNA-derived α,ω-dienes (M1–M3) were synthesized and engaged in acyclic-diene metathesis (ADMET) polymerization in a three-step study to prepare renewable aliphatic-aromatic polyesters (P1–P3). Furthermore, the results showed that the properties can be finely tuned depending on the monomer and catalyst loading. Thermal analysis demonstrated that the glass transition temperature (Tg) and the temperature at which 5% of the mass is lost (Td5%) varied depending on the alkene chain length. A general thermal trend was established: Tg(P1) > Tg(P2) > Tg(P3) and Td5%(P1) < Td5%(P2) < Td5%(P3).
The first step aimed to evaluate the activity of seven commercial metathesis catalysts for the solvent-free ADMET polymerization of M3. Although most of the studied catalysts exhibited good reactivity, the second-generation Hoveyda–Grubbs catalyst (C4) proved the best.
The second step was then started by varying the catalyst loading and testing M1 and M2 toward ADMET polymerization. Aliphatic-aromatic polyesters with a number-average molecular weight (Mn) up to 19.4 kDa (Đ = 1.88) were obtained. Furthermore, the results showed that the properties can be finely tuned depending on the monomer and catalyst loading. Thermal analysis demonstrated that the glass transition temperature (Tg) and the temperature at which 5% of the mass is lost (Td5%) varied depending on the alkene chain length. A general thermal trend was established: Tg(P1) > Tg(P2) > Tg(P3) and Td5%(P1) < Td5%(P2) < Td5%(P3).
The third step of the ADMET study was to evaluate the tolerance of M1–M3 and C4 toward Cyrene, a green and high boiling point solvent derived from cellulose. The results revealed that Cyrene merits further investigation as a “general” non-toxic solvent for ADMET polymerization of other monomers, particularly those with high melting points.
Evaluation of Gas-to-Liquid Transfer with Ceramic Membrane Sparger for H2 and CO2 Fermentation

Hydrogen and carbon dioxide fermentation to methane, called bio-methanation, is a promising way to provide renewable and easy-to-store energy. The main challenge of bio-methanation is the low gas-to-liquid transfer of hydrogen. Gas injection through a porous membrane can be used to obtain microbubbles and high gas-to-liquid transfer. However, the understanding of bubble formation using a membrane in the fermentation broth is still missing. This study focused on the impact of liquid pressure and flow rate in the membrane, gas flow rate, membrane hydrophobicity, surface, and pore size on the overall gas-to-liquid mass transfer coefficient (KLa) for hydrogen with gas injection through a porous membrane in real fermentation conditions. It has been shown that KLa increased by 13% with an increase in liquid pressure from 0.5 bar to 1.5 bar. The use of a hydrophilic membrane increased the KLa by 17% compared to the hydrophobic membrane. The membrane with a pore size of 0.1 µm produced a higher KLa value compared to 50 and 300 kDa. The liquid crossflow velocity did not impact the KLa in the studied range.
Insight into the Photodynamics of Photostabilizer Molecules

Solar exposure of avobenzone, one of the most widely used commercial UVA filters on the market, is known to cause significant degradation. This finding has fueled research into developing photostabilizer molecules. In an effort to provide insight into their stand-alone photoprotection properties, the excited state dynamics of the photostabilizer, 3-(3,4,5-trimethoxybenzylidene) pentane-2,4-dione (TMBP), and its phenolic derivative, 3-(4-hydroxy-3,5-dimethoxybenzylidene) pentane-2,4-dione (DMBP), were studied with ultrafast transient absorption spectroscopy. Solutions of TMPB and DMBP in ethanol and in an industry-standard emollient, as well as TMBP and DMBP deposited on synthetic skin mimic, were investigated. These experiments were allied with computational methods to aid interpretation of the experimental data. Upon photoexcitation, these photostabilizers repopulate the electronic ground state via nonradiative decay within a few picoseconds involving a twisted intramolecular charge transfer configuration in the excited state, followed by internal conversion and subsequent vibrational cooling in the ground state. This finding implies that, aside from acting as a photostabilizer to certain UV filters, TMBP and DMBP may offer additional photoprotection in a sunscreen formulation as a stand-alone UV filter. Finally, TMBP and DMBP could also find applications as molecular photon-to-heat converters.
Direct structural observation of ultrafast photoisomerization dynamics in sinapate esters

Sinapate esters have been extensively studied for their potential application in ‘nature-inspired’ photoprotection. There is general consensus that the relaxation mechanism of sinapate esters following photoexcitation with ultraviolet radiation is mediated by geometric isomerization. This has been largely inferred through indirect studies involving transient electronic absorption spectroscopy in conjunction with steady-state spectroscopies. However, to-date, there is no direct experimental evidence tracking the formation of the photoisomer in real-time. Using transient vibrational absorption spectroscopy, we report on the direct structural changes that occur upon photoexcitation, resulting in the photoisomer formation. Our mechanistic analysis predicts that, from the photoprepared ππ* state, internal conversion takes place through a conical intersection (CI) near the geometry of the initial isomer. Our calculations suggest that different CI topographies at relevant points on the seam of intersection may influence the isomerization yield. Altogether, we provide compelling evidence suggesting that a sinapate ester’s geometric isomerization can be a more complex dynamical process than originally thought.
An optimized semi-defined medium for p-coumaric acid production in extractive fermentation

In this study, the definition and optimization of a medium for cost-effective heterologous production as well as efficient recovery of the plant secondary metabolite p-coumaric acid (p-CA) was performed. Experimental designs were carried out to this end. First, a Plackett Burman design was used to choose the important factors that affect p-CA production. Then, a central composite face centered design was used to find the optima of the two major parameters, C/N ratio and pH. Finally, a four-component optimized semi-defined (OSD) medium was developed and experimented in both biphasic and control batch fermentations. In comparison to the results of previous biphasic fermentations work using a classic defined medium (a 2X Yeast Nitrogen Base medium without Amino Acids), OSD medium was 10 times less expensive per litre. At pH 4.5, the final p-CA production in OSD medium was approximately 61% of the p-CA content reached in the classic defined medium. At pH 6.0, the production of p-CA in OSD medium was 55% of the p-CA reached in the YNB medium.
Optimization of the Accelerated Solvent Extraction of Caffeoylquinic Acids from Forced Chicory Roots and Antioxidant Activity of the Resulting Extracts

Forced chicory roots (FCR) are the main but also the least valued by-products of Belgian endive culture. However, they contain molecules of interest for industry such as caffeoylquinic acids (CQAs). This study aims to investigate accelerated solvent extraction (ASE) as a green technique to recover chlorogenic acid (5-CQA) and 3,5-dicaffeoylquinic acid (3,5-diCQA), the main CQAs. A D-optimal design was used to determine the influence of temperature and ethanol percentage on their extraction. Optimal extraction conditions were determined using response surface methodology (RSM) and allow the recovery of 4.95 ± 0.48 mg/gDM of 5-CQA at 107 °C, 46% of ethanol and 5.41 ± 0.79 mg/gDM of 3,5-diCQA at 95 °C, 57% of ethanol. The antioxidant activity of the extracts was also optimized by RSM. The highest antioxidant activity was achieved at 115 °C with 40% ethanol (more than 22 mgTrolox/gDM). Finally, correlation between the antioxidant activity and the amount of CQAs was determined. FCR can be a great source of bioactive compounds with potential use as biobased antioxidant.
Analyse de tendance de la valorisation nationale des produits et coproduits végétaux

Pour accélérer la transition écologique de l'agriculture, une valorisation optimale des produits et co-produits végétaux qui en sont issus est nécessaire. Cette étude s'intéresse aux tendances à l’œuvre dans ce domaine, avec un accent particulier mis sur les protéines végétales
La diversification des systèmes de culture vers plus de légumineuses et plantes à fibres est une voie d’amélioration de la résilience économique et climatique des filières végétales. Néanmoins, au delà des contraintes agronomiques, leur développement dépendra en grande partie des opportunités de valorisation qui leur seront offertes.
Étude réalisée par Céresco, Bioeconomy For Change (ex-IAR) et AgroParisTech Innovation, et financée par le ministère de l'Agriculture et de la Souveraineté alimentaire.
Sustainability and efficiency assessment of vanillin allylation: in solution versus ball-milling

Allylation of phenols, a widely used reaction in multistep synthetic pathways, was herein investigated using mechanochemistry. This synthesis was first optimized on vanillin by varying key parameters including both chemical (e.g., stoichiometry, reaction time) and mechanical (e.g., rotational speed, material, size and number of beads, liquid additive) conditions, leading to the isolation of allylated vanillin at the gram scale in excellent yield (95%). The optimized procedure was also successfully implemented to another bio-based phenol of interest, ethyl ferulate (92% isolated yield). The environmental impact of these procedures was compared with more classical in-solution protocols by calculating E factors. When work-up solvents were not taken into account, E factor (sEF) clearly indicated the superiority of the ball-milling approach over the solution-based procedure, underscoring the capacity of ball-mills to drastically reduce the need for “reaction” solvents. On the other hand, when work-up solvents were taken into consideration, E factors (cEF) were in favor of the solvent-based approach, which could be explained by the solvent quantities required to recover the reaction mixture from the ball-mill reactor. Overall, these results highlight (i) the great potential of mechanochemistry to enable the development of both efficient and waste-less allylation of lignin-derived phenolic synthons, and (ii) the need to study higher-scale and continuous mechanochemical processes, such as by using extruders, to further improve efficiency and sustainability of such mechanochemical processes.
A sustainable preparative-scale chemo-enzymatic synthesis of 6-hydroxy-5,7-dimethoxy-2-naphthoic acid (DMNA) from sinapic acid

Naturally occurring sinapic acid is a valuable synthon for many high-value applications (e.g. cosmetic, pharmaceutic) that can be found in numerous plants, especially Brasiccacea species (e.g. rapeseed, mustard). It has been demonstrated that alkaline extraction of matter rich in sinapic acid resulted in the conversion of sinapic acid into 6-hydroxy-5,7-dimethoxy-2-naphtanoic acid (DMNA). Although DMNA could be a potential alternative to petro-based naphtanoic acid used in polymers, untill now, no reliable (bio)synthetic procedure existed to synthesize it at the preparative-scale. Herein, starting from sinapic acid, we describe a very simple one-pot two-step chemo-enzymatic pathway to DMNA – and reaction intermediaries bislactone (BL) and thomasidioic acid (TA) – at gram scale using a simple filtration as purification step. Green metrics – Process Mass Index and EcoScale – have been determined to assess the sustainability of this new process. Finally, the antiradical activities of DMNA, BL and TA have been evaluated.
Unlocking the access to oxidized coenzyme A via a single-step green membrane-based purification

A new membrane-based strategy to purify oxidized coenzyme A ((CoAS)2) from adenosine triphosphate (ATP), adenosine diphosphate (ADP) and adenosine monophosphate (AMP) has been developed. Commercially available membranes were screened and studied (permeate flux and overall compounds retention) which allowed the identification of one efficient membrane (GK from Suez Water Technologies & Solutions). Different total compounds concentrations solutions were used in the system in order to find the following working conditions: 4 bars with a total compounds solution of 5.19 g L−1.
Applying these conditions to a dia-filtration set-up allowed us to reach 68% pure (CoAS)2 in 4.8 diafiltration volumes (DV) and a 95% (CoAS)2 purity can be predicted in 8.5 DV. A comparative study of green metrics—i.e. process mass index (PMI)—of the classic chromatography vs the membrane-based one demonstrated the great advantages of the latter in terms of sustainability. This strategy unlocks the access to the essential and central cofactor that is coenzyme A.
Sustainable One-Pot Synthesis and Polycondensation of a Levoglucosenone-Derived Cyclic Acetal Diol

The already described one-pot two-step hydration/reduction of levoglucosenone (LGO) into (1R,2S,5R)-6,8-dioxabicyclo[3.2.1]octane-2,4-diol (HO-LGOL) was improved by replacing 50 mol % of Et3N by 5 mol % of K3PO4, a more sustainable base. The sterically hindered diol was then subjected to polycondensations with aliphatic comonomers to prepare new bio-based polyesters that exhibit glass transition (Tg) values between 12 and 54 °C and high thermal stability greater than 200 °C.
Two different strategies were implemented to perform the polymerizations: (1) utilization of aliphatic diacyl chlorides, or (2) a method involving aliphatic diethyl esters in the presence of a metal catalyst. These methods were then subjected to life cycle assessment to study their environmental impacts.
Mechanochemical synthesis of (4S)-N-alkyl-4,5-bis-sulfooxypentanamide via a one-pot sequential aminolysis-sulfation reaction of (S)-γ-hydroxymethyl-γ-butyrolactone (2H-HBO)

To valorize further the highly valuable bio-based platform (S)-γ-hydroxymethyl-γ-butyrolactone (2H-HBO), whose sustainable kiloscale-synthesis from cellulose-derived levoglucosenone (LGO) has been validated, a mechanochemical strategy was developed to produce new potential bio-based surfactants under solventless conditions. First, the reaction of 2H-HBO with primary or secondary amines was investigated followed by a sulfation reaction with the isolated N-alkyl-amide derivatives to obtain the corresponding N-alkyl sulfated compounds. The latter was then obtained by an optimized one-pot sequential aminolysis–sulfation in a planetary ball mill with excellent efficiency. For the first time, sulfated compounds arising from bio-based/renewable resources were obtained exclusively via a mechanochemical process. As a result, the sulfated derivatives of 2H-HBO were formed quantitatively and isolated in 69–79% overall yields. The critical micelle concentration (CMC) was determined for some of them which exhibited interesting anionic surfactant properties.
Optimization and Green Metrics Analysis of the AgOAc-Mediated Dimerization of Piceid: Toward a High-Yielding and More Sustainable Access to δ-Viniferin and Synthesis of New Piceid Dimers

Stilbenes are particularly studied for their biological properties. Among them, resveratrol and piceid, present in relatively large quantities in nature, have already demonstrated interesting characteristics. Dimers and oligomers of resveratrol are also very promising, especially, δ-viniferin for which an elegant synthetic method based on the hydrolysis of piceid dimer has been reported. Nevertheless, while the hydrolysis is quantitative, to date, the synthesis of the piceid dimer has only been described in the presence of laccase in toxic methanol and with a relatively average yield (46%). With a view to offering a greener and higher yielding dimerization of piceid, this study aims at (i) conducting the dimerization in the presence of AgOAc in ethanol, (ii) determining the influence of reaction parameters and the optimal conditions by using a Design of Experiment, (iii) assessing the EcoScale and process mass intensity (PMI) of the new procedure, and (iv) comparing it with the laccase-mediated procedure. Data demonstrated that the AgOAc-mediated dimerization of piceid proceeds in higher yield (ca. 64% vs 46%), with a better EcoScale (68 vs 32), while being more economical (PMI score = 2.5 vs 71.4) and using a green solvent (EtOH). Moreover, through this novel route, we were able to identify and fully characterize new dimers that were not reported in the literature so far.
Synthesis and Enzymatic Degradation of Sustainable Levoglucosenone-Derived Copolyesters with Renewable Citronellol Side Chains

Recently, a renewable five-membered lactone containing citronellol (HBO-citro) was synthesized from levoglucosenone (LGO). A one-pot two-step pathway was then developed to produce a mixture of 5- and 6-membered Lactol-citro molecules (5ML and 6ML, respectively) from HBO-citro. Proton nuclear magnetic resonance (1H NMR) of a mixture of 5ML and 6ML at varying temperatures showed that the chemical shifts of the hydroxyls, as well as the 5ML:6ML ratio, are temperature-dependent. Indeed, a high temperature, such as 65 °C, led to an up-field shielding of the hydroxyl protons as well as a drop in the 5ML:6ML ratio. The monomers 5ML and 6ML were then engaged in polycondensation reactions involving diacyl chlorides.
Renewable copolyesters with low glass transition temperatures (as low as −67 °C) and cross-linked citronellol chains were prepared. The polymers were then hydrolyzed using a commercial lipase from Thermomyces lanuginosus (Lipopan® 50 BG). A higher degradation rate was found for the polymers prepared using Lactol-citro molecules, compared to those obtained by the polycondensation reactions of diacyl chlorides with Triol-citro—a monomer recently obtained by the selective reduction of HBO-citro.
Green assessment of polymer microparticles production processes: a critical review

The fabrication of simple and core-shell polymer microparticles is of great importance due to their wide range of industrial applications, such as the food industry, cosmetics, and drug delivery. Regardless of their outstanding advantages, the vast majority of the targeted microparticles are produced using fossil raw materials whose depletion is inevitable, and there is an urgent need to develop innovative classes of sustainable microparticles from renewable resources. Several reviews discussed the common techniques to synthesize polymer microparticles for diverse real-life applications. Nonetheless, no reports were found on the sustainability evaluation of the diverse production methods or the microparticle raw materials and solvents used. In this critical review, the state of the art of polymer microparticles is first described. Next, the sustainability of the common production techniques, including microfluidics, is evaluated based on selected criteria, including waste generation, use of green solvents, atom- and energy efficiency. Furthermore, the challenges of achieving green production are discussed based on three elements: green production process, green raw material, and green solvents. Finally, room for improvement is discussed with highlights on future perspectives, including further investigations that should be accomplished to find renewable substitutes and green up the existing production strategies for better lives for future generations.
Phenolic Compounds Extracted from Cherry Tree (Prunus avium) Branches: Impact of the Process on Cosmetic Properties

Cherry tree branches (Prunus avium var burlat Rosaceae) are agricultural by-products that are often neglected, yet they are rich in phenolic compounds and highly appreciated for their numerous biological activities. Extracts of cherry tree branches were evaluated for their use in cosmetics, particularly for their antioxidant, anti-tyrosinase, and antimicrobial activities. Samples were obtained by accelerated solvent extraction (ASE) at different ethanol percentages and different temperatures. Fourteen phenolic compounds were identified in the extracts by mass spectrometry. Three major compounds were identified (catechin, genistin, and prunin) representing 84 wt% of the total phenolic compounds. Optimal operating conditions maximizing the content of phenolic compounds were determined using a one factor at a time (OFAT) approach (70% aqueous ethanol, 70 °C). The extract obtained under these conditions also showed the highest antioxidant and anti-tyrosinase activities, certainly due to a high catechin content. Although the antimicrobial activities of extracts are less versatile than those of synthetic molecules, they are nonetheless interesting. According to these results, the extracts of cherry tree branches could be used in cosmetics for their interesting properties.
Optimization of Extraction Conditions to Improve Chlorogenic Acid Content and Antioxidant Activity of Extracts from Forced Witloof Chicory Roots

Chlorogenic acids are major phenolic constituents in many herbal medicines and exhibit various bioactivities that explain the growing interest in extracting chlorogenic acids from biomass. In this context, the present study aims to maximize 3-O-Caffeoylquinic acid (3-CQA) and 3,5-O-di-caffeoylquinic acid (3,5-diCQA) contents from forced witloof chicory roots and to analyze the extraction kinetic modelling. First, the solid–liquid ratio, ethanol concentration, extraction time and temperature were studied. The extraction conditions were optimized to maximize the extraction of these compounds. The maximum yields reached 5 ± 0.11 and 5.97 ± 0.30 mg/g dry matter (DM) for 3-O-Caffeoylquinic acid and 3,5-O-di-caffeoylquinic acid, respectively, in less than 6 min at 70 °C. Extraction with water as a solvent was assessed with the aim of proposing a second greener and less-expensive solvent. This extraction is very fast from 90 °C, with a maximum of 6.22 ± 0.18 mg/gDM of 3-O-Caffeoylquinic acid, and instantaneous for 3,5-O-di-caffeoylquinic acid with a maximum of 6.44 ± 0.59 mg/gDM. In the second step, response surface methodology was employed to optimize the ultrasound-assisted extraction of antioxidants. The higher antioxidant activities were found at temperatures from 40 °C and at percentages of ethanol in the range of 35–70%.
In-stream product recovery of p-coumaric acid heterologously produced: implementation of a continuous liquid-liquid extraction assisted by hollow fiber membrane contactor

This work aims to intensify trans-p-coumaric acid (p-CA) heterologous production. p-CA exhibits antimicrobial properties, low hydrosolubility, and retro-inhibition activity, making its heterologous production limited due to its accumulation in the broth. To overcome these limitations, an in-stream product recovery process (ISPR) is proposed and consists in a liquid-liquid extraction assisted by a hollow fiber membrane contactor. pH, medium composition, and solvent impacts on extraction performances, were investigated prior to the implementation. The coupling of the fermentation and the membrane-assisted extraction was then investigated. Although cells were impaired by shear stress with only 15% of viable cells at the end in the extractive fermentation, the final p-CA concentration was approximatively 89% of the control one, suggesting an intensification of p-CA heterologous production if one factors the proportion of viable cells.
Evaluation of the Potential of Lipid-Extracted Chlorella vulgaris Residue for Yarrowia lipolytica Growth at Different pH Levels

Projections show that the cultivation of microalgae will extend to the production of bio-based compounds, such as biofuels, cosmetics, and medicines. This will generate co-products or residues that will need to be valorized to reduce the environmental impact and the cost of the process. This study explored the ability of lipid-extracted Chlorella vulgaris residue as a sole carbon and nitrogen source for growing oleaginous yeasts without any pretreatment. Both wild-type Yarrowia lipolytica W29 and mutant JMY3501 (which was designed to accumulate more lipids without their remobilization or degradation) showed a similar growth rate of 0.28 h−1 at different pH levels (3.5, 5.5, and 7.5). However, the W29 cell growth had the best cell number on microalgal residue at a pH of 7.5, while three times fewer cells were produced at all pH levels when JMY3501 was grown on microalgal residue. The JMY3501 growth curves were similar at pH 3.5, 5.5, and 7.5, while the fatty-acid composition differed significantly, with an accumulation of α-linolenic acid on microalgal residue at a pH of 7.5. Our results demonstrate the potential valorization of Chlorella vulgaris residue for Yarrowia lipolytica growth and the positive effect of a pH of 7.5 on the fatty acid profile.
Impact of Bis-O-dihydroferuloyl-1,4-butanediol Content on the Chemical, Enzymatic and Fungal Degradation Processes of Poly(3-hydroxybutyrate)

Poly-β-hydroxybutyrate (PHB) is a very common bio-based and biocompatible polymer obtained from the fermentation of soil bacteria. Due to its important crystallinity, PHB is extremely brittle in nature, which results in poor mechanical properties with low extension at the break. To overcome these issues, the crystallinity of PHB can be reduced by blending with plasticizers such as ferulic acid derivatives, e.g., bis-O-dihydroferuloyl-1,4-butanediol (BDF). The degradation potential of polymer blends of PHB containing various percentages (0, 5, 10, 20, and 40 w%) of BDF was investigated through chemical, enzymatic and fungal pathways. Chemical degradation revealed that, in 0.25 M NaOH solution, the presence of BDF in the blend was necessary to carry out the degradation, which increased as the BDF percentage increased. Whereas no enzymatic degradation could be achieved in the tested conditions. Fungal degradation was achieved with a strain isolated from the soil and monitored through imagery processing. Similar to the chemical degradation, higher BDF content resulted in higher degradation by the fungus.
Fully renewable photocrosslinkable polycarbonates from cellulose-derived monomers

Cellulose-derived photocrosslinkable polycarbonates (PCs) with renewable citronellol pendant chains were synthesised through the polycondensation of Triol-citro, a recently developed levoglucosenone-based triol monomer, and dimethoxycarbonyl isosorbide. The polymer structures were unveiled through NMR spectroscopy and four repeating units were identified: three hydroxy-functional linear units (Ln, Lo and Lp) and one dendritic unit (Dq). The relative percentages of the repeating units, as well as the molecular weights of the corresponding polymers, can be finely tuned by varying the catalyst and reaction conditions (i.e., polycondensation temperature and monomer concentration). Thermal analyses demonstrated that the novel PCs exhibited low glass transition temperatures (Tg as low as -72 °C) and good thermal stability (Td5% up to 159 °C). These hydroxy-functionalised PCs are not only fully biobased with a controlled extent of branching, but they also bear citronellol side chains that were successfully crosslinked via ultraviolet irradiation to further control the polymer properties.
Improved Processability and Antioxidant Behavior of Poly(3-hydroxybutyrate) in Presence of Ferulic Acid-Based Additives

Poly(3-hydroxybutyrate), PHB, has gathered a lot of attention for its promising properties—in particular its biobased nature and high biodegradability. Although PHB is prime candidate for the packaging industry, the applications are still limited by a narrow processing window and thermal degradation during melt processing. In this work, three novel additives based on ferulic acid esterified with butanediol, pentanediol, and glycerol (BDF, PDF, and GTF, respectively) were used as plasticizers and antioxidative additives to improve mechanical properties of PHB. Elongation at break up to 270% was obtained in presence of BDF and the processing window was improved nearly 10-fold. The Pawley method was used to identify the monoclinic space group P2 of the BDF. The estimated crystallite size (71 nm) agrees with a crystalline additive. With PHB70BDF30 blends, even higher elongations at break were obtained though dwindled with time. However, these properties could be recovered after thermal treatment. The high thermal stability of this additive leads to an increase in the fire retardancy property of the material, and the phenolic structure induced antioxidant properties to the samples as demonstrated by radical scavenging tests, further highlighting the possibilities of the PHB/additive blends for packaging applications.
Optimization of the Recovery of Secondary Metabolites from Defatted Brassica carinata Meal and Its Effects on the Extractability and Functional Properties of Proteins

The sustainable extraction of secondary metabolites from Brassica agro-industrial by-products often involves the use of high concentrations of ethanol, and/or high temperatures, which tends to decrease the efficiency of protein extraction (yield, profile, etc.). To understand the limits of the combination of these two extraction processes, aqueous ethanol extraction of secondary metabolites (e.g., phenolic compounds and glucosinolates) from Brassica carinata defatted meal was optimized using Response Surface Methodology. The validated models predicted that aqueous ethanol extraction of defatted Carinata meal, with a low aqueous EtOH concentration (22% EtOH) at moderate Te (50 °C), enables the efficient recovery of secondary metabolites (sinapine = 9.12 ± 0.05 mg/gDM, sinigrin = 86.54 ± 3.18 µmol/gDM) while maintaining good protein extractability (59.8 ± 2.1%) from successive alkaline extractions. The evaluation of functional properties of the resulting protein isolates revealed that aqueous extraction, under optimized conditions, improves foaming activity while preserving emulsion ability.
Sustainable synthesis, in silico evaluation of potential toxicity and environmental fate, antioxidant and UV-filtering/photostability activity of phenolic-based thiobarbituric derivatives

The recent ban of some organic UV-filters – such as oxybenzone or octinoxate – considered toxic for coral reef, has heightened the need for eco-friendly alternatives, especially those synthesized using green approaches that reduce the carbon footprint. In this context, several thiobarbituric acid derivatives were synthetized from bio-based p-hydroxybenzaldehydes (e.g. vanillin, syringaldehyde) through a high-yielding sustainable Knoevenagel condensation, and their UV-filtering activity, stability and antiradical properties were investigated. The results showed promising UVA and blue light coverage over time, as well as competitive EC50 values in comparison to commercial antioxidants (i.e. BHA and BHT). In order to evaluate the potential of these molecules as substitutes to current petroleum-based UV-filters, the potential toxicity and fate in environment of these new compounds were evaluated in silico. This screening did not show a critical potential for toxicity, making them promising candidates for further in vitro and in vivo assessment.
Unprecedented Biodegradable Cellulose-Derived Polyesters with Pendant Citronellol Moieties: From Monomer Synthesis to Enzymatic Degradation

Levoglucosenone (LGO) is a cellulose-derived molecule that is present commercially on a multi-ton/year scale. Taking advantage of the α,β-conjugated ketone of LGO, a new citronellol-containing 5-membered lactone (HBO-citro) was synthesized through a one-pot two-step pathway involving oxa-Michael addition and Baeyer-Villiger oxidation. The solvent-free treatment of HBO-citro with NaBH4 at room temperature led to the full reduction of the lactone moiety which gave a novel fully renewable triol monomer having a citronellol side chain (Triol-citro). Noticeably, by simply changing the reducing agent, temperature and reaction duration, the partial reduction of HBO-citro can be achieved to yield a mixture of 5- and 6-membered Lactol-citro molecules. Triol-citro was chosen to prepare functional renewable polyesters having citronellol pendant chains via polycondensation reactions with diacyl chlorides having different chain lengths. Good thermal stability (Td5% up to 170 °C) and low glass transition temperatures (as low as −42 °C) were registered for the polyesters obtained. The polymers were then hydrolyzed using a commercial lipase from Thermomyces lanuginosus (Lipopan® 50 BG) to assess their biodegradability. A higher degradation profile was found for the polyesters prepared using co-monomers (acyl chlorides) having longer chain lengths. This is likely due to the decreased steric hindrance around the ester bonds which allowed enhanced accessibility of the enzyme.
Photocatalytic Radical Addition to Levoglucosenone

Using photocatalysis with tetra-n-butylammonium decatungstate (TBADT), alkanes, cyclic acetals, cyclic ethers, formamide and aldehydes were added in a stereoselective way to levoglucosenone (LGO). A hydrogen atom is transferred from the donor compound to the photochemically excited TBADT, and the resulting radicals add onto LGO in a stereoselective way. In the case of the addition of adamantane, two regio-isomers were obtained which form a crystalline solid solution. Cyrene™, obtained by hydrogenation of LGO, was added under the same conditions. In this case, only two of 32 possible isomers of the resulting Cyrene™ dimer were formed. The regio-selectivity of the HAT step is discussed in detail. For this purpose, bond dissociation energies and partial charges have been calculated. Transition state calculations of the radical addition to LGO explain the stereospecificity of this reaction step.
Predictive modeling and experimental implementation of organic acids in stream recovery by reactive extraction in membrane contactors
Membrane-based reactive extraction as an in situ product recovery technique is a promising strategy for process intensification, in particular in the case of the bioproduction of organic acids. Reactive extraction allows a high selectivity for the extraction of the targeted acid and the microporous membrane keeps biocatalysts in the aqueous broth while implementing a large liquid-liquid surface area and ensuring a dispersion-free contact, without problems of emulsion formation. This paper deals specifically with the extraction of biobased 3-hydroxypropionic acid using tri-n-octylamine in n-decanol. In order to maintain an effective driving force for 3-HP transfer into the organic phase, this latter was continuously regenerated by recovering the acid in a back-extraction aqueous phase, giving a complete pertraction process. A mass transfer model for this process was developed. It is based on the boundary layer theory and takes into account chemical and physical equilibria of complexation/dissociation and partitioning, species diffusion in the membrane pores and viscosity variations in the organic phase. Viscosity highly depends on acid concentration, increasing up to 50% when 3-HP concentration reaches 28 g.L-1. Thus, it was possible to predict different experimental results with R2 ≥ 0.99, totally neglecting chemical kinetics and interfacial resistance for both extraction and back-extraction steps. The model allows the prediction of extraction kinetics with (1) fixed initial concentrations and (2) with gradual 3-HP feed (mimicking a bioconversion) in transient and steady states coupled with back-extraction (globally also called pertraction). Model based analysis of mass transfer mechanisms led to the construction of a nomogram giving 3-HP stationary concentration in the case of a typical production rate, enabling for example a rapid organic phase selection or membrane sizing.
Extraction and Purification Processes of Sinapic Acid Derivatives from Rapeseed and Mustard Seed By-Products

By-products obtained through the industrial processing of rapeseed and mustard seeds are exploited as feed or methanization. However they contain high added value phenolic compounds, such as sinapic acid and its derivatives, that could be recovered by extraction and purification processes. This review presents the state of the art on such recovery processes. It covers conventional extraction by solvent and emergent extraction processes, namely solvent extraction assisted by ultrasound, microwaves, pressure, electro-technologies or enzymes. Concerning the purification processes, liquid-liquid extraction, adsorption and membrane filtration processes are commonly implemented. This article summarizes the most promising methods and technologies for developing sustainable processes for the recovery of sinapic acid derivatives from rapeseed and mustard seed by-products.
Bio-based photo-reversible self-healing polymer designed from lignin

Lignocellulose-derived p-hydroxycinnamic acids possess the photo-responsive reversible α,β-unsaturated ester moiety, a reactive structural feature that functions as the basis of the photo-reversible [2 + 2] cycloaddition reaction. To explore the potential of these naturally occurring compounds in the field of self-healing materials, novel bio-based photo-crosslinkable lignin- and glycerol-derived polyfunctional monomers having cinnamate groups were produced using a sustainable process from vanillin and syringaldehyde, two compounds readily obtained from the oxidation of lignin. Through a Structure–Activity Relationship (SAR) study, the structural design of these bio-based monomers was optimized with regards to the crosslinking/decrosslinking extent and the self-healing capacity of the corresponding polymer material. The lignin- and glycerol-derived tri-functional monomer with 4-O-propyl-ferulate moieties has facilitated the design of a new family of bio-based, environment-friendly and reversible self-healing materials for widespread applications. Computational density-functional theory (DFT) and time-dependent DFT calculations were further used for the verification of the SAR study in terms of dimerization energy of the synthesized monomers.
Towards Developing Novel and Sustainable Molecular Light-to-Heat Converters

Light-to-heat conversion materials generate great interest due to their widespread applications, notable exemplars being solar energy harvesting and photoprotection. Another more recently identified potential application for such material is in molecular heaters for agriculture, whose function is to protect crops from extreme cold weather and extend both the growing season and the geographic areas capable of supporting growth, all of which could help reduce food security challenges. To address this demand, a new series of phenolic-based barbituric absorbers of ultraviolet (UV) radiation has been designed and synthesised in a sustainable manner. The photophysics of these molecules has been studied in solution using femtosecond transient electronic and vibrational absorption spectroscopies, allied with computational simulations and their potential toxicity assessed by insilico studies. Following photoexcitation to the lowest singlet excited state, these barbituric absorbers repopulate the electronic ground state with high fidelity on an ultrafast time scale (within a few picoseconds). The energy relaxation pathway includes a twisted intramolecular charge-transfer state as the system evolves out of the Franck-Condon region, internal conversion to the ground electronic state, and subsequent vibrational cooling. These barbituric absorbers display promising light-to-heat conversion capabilities, are predicted to be non-toxic, and demand further study within neighbouring application-based fields.
Simultaneous extraction and enzymatic hydrolysis of mustard bran for the recovery of sinapic acid

The simultaneous extraction and enzymatic hydrolysis of sinapine from a mustard residue was designed for the recovery of sinapic acid, a high value-added phenolic acid. An initial screening allowed the identification of sinapoyl esterase activities in commercial enzymatic cocktails (Depol 740 L, Ultraflo XL, Deltazym VR AC-100, Pectinase-PL “Amano”) and in a mono-enzymatic solution of rumen feruloyl esterase. These enzymatic cocktails were not very tolerant to ethanol with a diminution of 70 to 90% of the activity in presence of 10% (v/v) of ethanol. Different extraction processes on mustard bran were designed depending on the solvent compositions (ethanol 70% (v/v), water with or without sinapoyl esterase), pH (4.3, 7 or 12) and temperatures (50, 75 or 100 °C). Their respective efficiencies were discussed. The implementation of Depol 740 L in water allowed to recover 68% of the accessible sinapic acid (25.4 ± 0.1 µmol/g of bran dry matter) in 2h40 min under mild conditions (pH 7, 50 °C). This efficient biocatalytic production of sinapic acid from mustard feedstock using an enzymatic cocktail paves the way for new developments for the design of an industrial process.
Amanita muscaria: Ecology, Chemistry, Myths

Amanita muscaria is the most emblematic mushroom in the popular representation. It is an ectomycorrhizal fungus endemic to the cold ecosystems of the northern hemisphere. The basidiocarp contains isoxazoles compounds that have specific actions on the central nervous system, including hallucinations. For this reason, it is considered an important entheogenic mushroom in different cultures whose remnants are still visible in some modern-day European traditions. In Siberian civilizations, it has been consumed for religious and recreational purposes for millennia, as it was the only inebriant in this region.
Green synthesis of 2-deoxy-D-ribonolactone from cellulose-derived levoglucosenone (LGO): a promising monomer for novel bio-based polyesters

The already reported, yet hazardous, Et3N-catalyzed levoglucosenone (LGO) hydration into 1,6-anhydro-3-deoxy-β-D-erythro-hexo-pyranose-2-ulose (LGO-OH) has been greened up by substituting Et3N with K3PO4 and performing the reaction in H2O. Optimal reaction conditions (K3PO4 (0.05 eq.), [LGO] = 0.08 M, 5 h) not only allowed higher yields, but also limited the homocoupling of LGO, a competitive side reaction. A comparative – yet non-comprehensive and perfectible – Life Cycle Assessment (LCA) using the CML 2002 method highlighted the specific impacts where this revisited synthesis outperformed the Et3N-catalyzed one. 1,6-Anhydro-3-deoxy-β-D-erythro-hexo-pyranose-2-ulose was then subjected to a one-pot catalyst- and organic solvent-free Baeyer-Villiger oxidation/rearrangement, without the need to perform acidic hydrolysis, to access 2-deoxy-D-ribonolactone (HO-HBO, 79% yield). To assess the potential of HO-HBO as monomer for the production of novel bio-based polyesters, the latter was finally polymerized in the presence of aliphatic diacyl chlorides to make a proof-of-concept. Resulting polyesters exhibited promising glass transition temperature (Tg) values between -21 and -2 °C and melting temperatures (Tm) from 87 to 144 °C, demonstrating the potential of HO-HBO for the production of sustainable alternatives to current fossil-based polymers.
Nanocrystallisation and Self-Assembly of Biosourced Ferulic Acid Derivative in Polylactic Acid Elastomeric Blends

Hypothesis: The crystallisation of biosourced ferulic acid derivatives - Bis-O-feruloyl-1,4-butanediol (BDF) - in a polylactic acid (PLA) matrix produces thermoplastic elastomeric blends that are transparent and biodegradable. Elastomeric and transparency are controlled by the domain size. PLA-BDF blends up to a threshold BDF concentration providing elastomeric properties show no evidence of BDF crystallisation. Heat treatment weakens the PLA-BDF interaction, give BDF molecules mobility to interact with nearby BDF molecules, leading to BDF nano-crystallisation.
Experiments: PLA-BDF blends were synthesised by hot-melt processing by mixing pure PLA with different concentrations of BDF (0-40 wt%) at 180 °C for 13 minutes. One set of blends was annealed at 50 °C for 24 h and compared with the unannealed set. The BDF crystallisation in the blends is studied by combining SAXS, SEM, XRD and Polarised Optical Microscopy. Monte-Carlo simulations were performed to validate SAXS data analysis.
Findings: Unannealed PLA-BDF blends of up to the threshold of 20 wt% BDF are dominated by the semicrystalline behaviour of PLA, without any trace of BDF crystallisation. Surprisingly, the PLA-BDF 40 wt% blend shows BDF crystallisation in the form of large and nanoscale structures bonded together by weak interparticle interaction. At concentrations up to 20 wt%, the BDF molecules are homogenously dispersed and bonded with PLA. Increasing BDF to 40 wt% brings the BDF molecules close enough to crystallise at room temperature, as the BDF molecules are still bonded with the PLA network.
Annealing of PLA-BDF blends led to BDF nanocrystallisation and self-assembling in the PLA network. Both BDF nanoparticle size and interparticle distance decrease as the BDF concentration increases. However, the number density of BDF nanocrystals increases. The formed BDF nanocrystals have size ranging between 100 and 380 Å with interparticle distance of 120-180 Å. The structure factor and potential mean force confirm the strong interparticle interaction at the higher BDF concentration. Heat treatment weakens the PLA -BDF interaction, which provides mobility to the BDF molecules to change conformation and interact with the nearby BDF molecules, leading to BDF crystallisation. This novel BDF crystallisation and self-assembly mechanism can be used to develop biodegradable shape memory PLA blends for biomedical, shape memory, packaging and energy applications.
Diethyl sinapate-grafted cellulose nanocrystals as nature-inspired UV-filters in cosmetic formulations

Inspired by nature’s photoprotection mechanisms, we report an effective UV-blocking nanomaterial based on diethyl sinapate-grafted cellulose nanocrystals (CNC-DES). The colloidal stability and UV-blocking performance of CNC-DES in aqueous glycerol (a common humectant in petroleum-free cosmetic formulations) and in a commercially-available moisturising cream were studied. Grafting the water-insoluble DES onto CNCs renders it dispersible in these water-based formulations, thanks to the excellent water-dispersibility of CNC nanoparticles. Glycerol dispersions containing 0.1 to 1.5 wt% CNC-DES display very high UV-blocking activity owing to the anti-UV DES moieties anchored onto CNCs. A facial cream blended with 1.5 wt% CNC-DES exhibits an SPF of 5.03, which is higher than a commercially-available sunscreen with the same active ingredient concentration (SPF = 3.84). DPPH radical scavenging assay also showed the antioxidant potential of CNC-DES, albeit coinciding with a significant reduction in antioxidant activity after grafting DES onto CNCs. Cytotoxicity measurements revealed the CNC-DES not to cause significant cytotoxicity to murine fibroblast cells after 24 h of exposure. Overall, CNC-DES exhibits strong anti-UV and antioxidant properties and is water-dispersible, biocompatible, non-greasy, and light-weight. This study demonstrates the exceptional potential of DES-grafted CNCs as nature-inspired UV-filters in the next generation of cosmetic formulations, including those for sensitive skins.
Barbecue: The Chemistry behind Cooking on a Barbecue

New Book Chapter !
Summer is not only the time for everyone to enjoy the sun; it also gets us excited about the mouthwatering smoky taste of barbecued food. Although everyone agrees that charcoal- and wood-grilled food is delicious, few really appreciate the chemistry behind the great smoky flavour of barbecued meat. When wood and charcoal burn, cellulose, hemicelluloses and lignins are thermally degraded. Lignins are responsible for the smoky flavour; indeed, a variety of phenolic compounds are generated through the oxidative degradation of lignins via pyrolysis. Wood and charcoal have been proven to play a crucial role in the production of the smoky taste and smell; however, the glycation reactions sometimes called Maillard reactions also strongly contribute to the delicious flavour of grilled food. Moreover, these also provide the grilled meat with the characteristic brown colour. Although wood- and charcoal-grilling brings delicious smoky flavour and smell to the meat, it can also generate harmful chemicals.
https://www.taylorfrancis.com/chapters/edit/10.1201/9780429168703-13/barbecue-chemistry-behind-cooking-barbecue-florent-allais
Sustainable Hyperbranched Functional Materials via Green Polymerization of Readily Accessible Levoglucosenone-Derived Monomers

The homopolymerization in basic conditions of the recently reported bis(γ-lactone), 2H-HBO-HBO, is herein described for the first time. The solvent-free polymerization of this pentafunctional levoglucosenone (LGO) derivative afforded fully renewable poly(vinyl-ether lactone) copolymers with a highly hyperbranched structure. This investigation stemmed from the polycondensation trials between 2H-HBO-HBO and di(methyl carbonate) isosorbide (DCI) that failed to give the anticipated polycarbonates. Such unexpected behavior was ascribed to the higher reactivity of the 2H-HBO-HBO hydroxy groups towards its α,β-conjugated endocyclic C = C, rather than the DCI methylcarbonate moieties. The different mechanistic scenarios involved in 2H-HBO-HBO homopolymerization have been addressed and a possible structure of poly(2H-HBO-HBO) was suggested. Furthermore, the readily accessible (S)-γ-hydroxymethyl-α,β-butenolide (HBO) was also polymerized for the first time at a relatively large-scale, without any prior modification, resulting in a new hyperbranched polymer with an environmental factor (E factor) ∼ 0. These new HBO-based polymers have a great potential for industrial-scale production due to their interesting properties and easy preparation via a low-cost, green and efficient process.
Comprehensive lipid profiling of Microchloropsis gaditana by liquid chromatography - (tandem) mass spectrometry: Bead milling and extraction solvent effects

Liquid chromatography - mass spectrometry (LC-MS) experiments were used to qualitatively and semi-quantitatively monitor the impact of bead milling and the influence of the nature of the extraction solvents, Bligh and Dyer (B&D) versus n-heptane, on the composition of the structural lipids extracted from the microalgae Microchloropsis gaditana (M. gaditana).